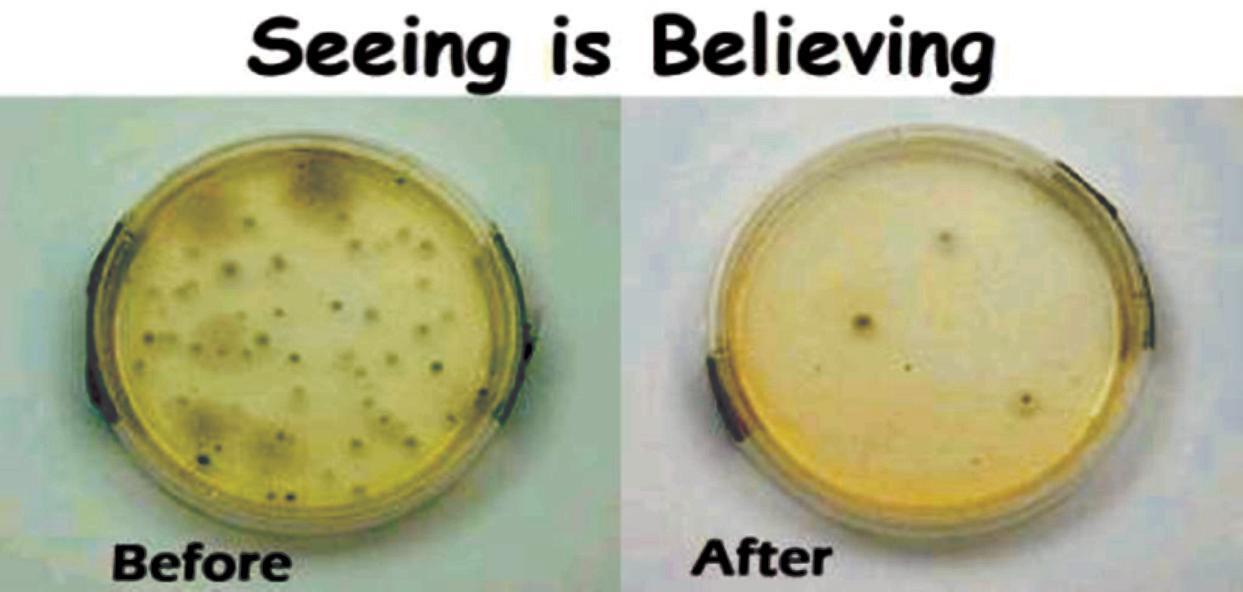

![]()



By Ron Bukley Town-Crier Staff Report
Members of the Royal Palm Covenant Church in Royal Palm Beach presented a certificate of appreciation Wednesday to Capt. Tony Araujo of the Palm Beach County Sheriff’s Office to thank him and his staff at the District 9 substation for their support of church activities. Araujo, the village’s top law enforcement officer, accepted the certificate during Wednesday’s meeting of the Royal Palm Beach Village Council.

Beach, Head To Regional Finals
The Royal Palm Beach High School football team continued its winning ways last Friday night in Vero Beach, defeating the Fighting Indians 28-13 in the regional semifinals and setting up a home contest this Friday against defending 6A state runner-up Orlando Boone High School. Page 27
Business

Cool Deals On Service And Installation At Sea Breeze Air Systems Palm Beach County residents who want friendly and honest air conditioning installation and service should check out Sea Breeze Air Systems, owners Nancy and Terry Cook said. Terry Cook has been working in the air conditioning field since 1967. Page 32
“You have been working well with us over the past few years with our Youth Explosion and different things that we have been putting on,” Pastor Mike Rose said. “We couldn’t do it without you, and we want to say thank you very, very much for your support.”
Youth Leader Triashanna Gifford thanked the council for the opportunity to show the church’s appreciation of PBSO
support and read a letter addressed to Araujo.
“Thank you so much for the support you showed for our recent Youth Explosion 2008,” she read. “More than once you have lent your support and expertise in an effort to educate parents and youth of our community. Also, this past Thanksgiving you partnered with us to distribute 235 turkey or chicken baskets. Your generosity, compassion and willingness to help never ceases to amaze us. It is a major blessing to our community. You have been a lifeline to our community.”
Rose said he found partnering with Araujo and his staff to be a blessing. “The sheriff’s department has put on some great seminars that have enlightened me and my family and bring some awareness to the families who are participating — things that you don’t know about unless you go and see what’s available to help you and your

By Ron Bukley Town-Crier Staff Report
The Palm Beach County Commission parried the objections of about 100 people Tuesday to approve the county’s fiveyear road plan with the Roebuck Road extension intact. While the extension of Roebuck Road from Jog Road west to Royal Palm Beach is intended to decrease congestion on Okeechobee Blvd., the commissioners followed through on county plans to remove road improvements in and around The Acreage from its five-year schedule of projects. Indian Trail Improvement District President Mike Erickson suggested the county shift some of the Roebuck Road funding, estimated at about $54 million, toward the widening of Seminole-Pratt Whitney Road, which was part of $20 million in Acreage roadwork projects removed from the five-year plan and was part of $28 million in
transportation money put into mass transit at the direction of the commission.
“$20 million was removed from our area,” Erickson said. “I do support mass transit, but we have a real problem out west. It’s another problem when the engineer says there will be no problem for five years. What about the next 20 years?”
Erickson said construction vehicles hauling rock from Palm Beach Aggregates on two-lane roads in The Acreage increase traffic hazards there. He also asked commissioners to consider extending two lanes of Seminole Pratt Whitney Road northward from Northlake Blvd. to the Beeline Highway and the industrial areas at the Palm Beach Park of Commerce.
Improvements to Seminole Pratt would encourage more north/south trips that now go east and west, Erickson said. “Let’s find the funding,” he implored.
By Ron Bukley
Town-Crier Staff Report
Wellington’s Planning, Zoning & Adjustment board decided by consensus Thursday to ask that village staff reconsider the scope of a proposed ordinance that would allow some property owners in the village’s Paddock Park 1 neighborhood to build stables.
Horse stables are currently allowed only in the Equestrian Preserve Area (EPA) in western and southern Wellington, where large lots and equestrian-centered homes and businesses predominate.
The Paddock Park 1 neighborhood, which is north of the EPA, has generally smaller lots. Village staff members told the board that the neighborhood was seen as moving away from equestrian development when the EPA’s boundaries were established, and it was excluded. About a dozen residents at the meeting spoke both for and against the amendment, including 12-year-old Paddock Park resident and rider Madison Boyd, who launched an effort to reinstate the ability to build stables in her neighborhood.
youngster when you are in crisis.”
Rose said PBSO personnel also volunteered at the church, helping pack and deliver Thanksgiving baskets. “It’s awesome that you find a sheriff’s department ready and willing to engage in helping the community,” he said.
Araujo was humbled to receive the certificate of appreciation but credited the officers on his staff with being the real force behind the community service.
“This is a credit not to me, but to the officers, the majority of them former Royal Palm Beach officers,” Araujo said. “We’ve talked about community policing. We made that commitment to this community, and it’s about those acts of service beyond the act of policing, which brings successes, sometimes one at a time, sometimes a few at a time, but that’s what it’s about.”
Araujo said his department partners with religious groups across the community to provide whatever service is needed.
“We just had our yearly meeting with them,” he said. “They do a tremendous job supporting us, but I can tell you that Pastor Rose is in the trenches every day. We’ve called to him to help us. Sometimes social services aren’t available to us at three in the morning. He is. And there’s also a food pantry there, which we help to stock, but anybody in our community who wants to donate to a good cause, Covenant Church here in Royal Palm helps a lot of families through rough times.”
For more information about making food donations, call Royal Palm Covenant Church at (561) 793-1077.
CityWatch President Dr. Len Fentzi said bridging Roebuck Road as recommended by the South Florida Water Management District to allow a flow way and wildlife passage could escalate the cost to $100 million.
“You should know your budget has already increased $20 million to $52.4 million,” Fentzi said. “I don’t think that is going to be enough. You don’t need engineering to tell you that Okeechobee Blvd. is being widened. Traffic is down on Okeechobee almost ten percent. The Acreage no longer supports Roebuck Road. Why is the commission so hell-bent on supporting a road that goes nowhere?”
Acreage Landowners’ Association President Bob Renna said his organization opposes the county’s five-year road plan because it favors Roebuck Road over postponed local projects including work on Seminole Pratt and Northlake.
“We’re calling for the exten-
The draft ordinance reviewed Thursday would have allowed small stables on 37 lots in Paddock Park 1 that had lost that right in 2003. The eligible lots all have direct access to an equestrian trail, cover one acre or more and also abut lots of at least an acre, according to the staff report. “We went back and looked at areas that might be affected,” Community Development Director Marty Hodgkins said. “Essentially, as the draft ordinance is written, the only areas are 37 lots on the west and north side of Paddock Park.”
Other lots farther east were not included because they do not abut a bridle path, are less than an acre in size or abut lots of less than an acre, Hodgkins said.
The ordinance would limit the number of stables on a lot to two and covering no more than 1,250 square feet per acre. Groom’s quarters would not be permitted in order to deter commercial activities.
Some PZA Board members said they were concerned about adding horses to lots where residents already depend on septic tanks and well water.
Board Member Eugene DiFonte asked how many horses would be allowed per acre, and Village Attorney Jeff Kurtz said there is no restriction on the number of horses, only the number of stalls.
“The ordinance as written is dealing with stalls, not horses,” DiFonte said. “I love horses. I like the idea of permitting stables there, but I see where you’re going.”
During public comments, Madison Boyd’s father Al said his daughter had been riding since age three. They live along the canal on the north end of Paddock Park 1 on a 1.17-acre lot. “We moved into Paddock Park in 2001 with the intention of putting in stalls,” he said.
Boyd said he talked to others in the neighborhood who had stalls built prior to them being prohibited in 2003, including one neighbor with two stalls featuring beautiful architecture. Boyd said he felt it is unfortunate to see equestrian uses zoned out in an area that takes pride in horses. “It doesn’t make a lot of sense,” he said.
Boyd added that he was previously unaware that the law had been changed to prohibit building stalls in his neighborhood. Pacer Circle resident Andy Langsam told the board he lives on a lot far larger than one acre, but he had been excluded from the proposed ordinance.
“The valuation of homes with stables is higher,” Langsam said, See STABLES, page 18

sion of Seminole Pratt,” Renna said. “We as residents want the widening of Seminole Pratt. We strongly recommend you consider doing those things. We share Seminole Pratt with semis and dump trucks that use Seminole Pratt as a cut-through…. There are so many things the county could do with this money. Why in these times would you build a road that benefits only a few?”
Riverwalk Homeowners’ Association President Jim Greene, whose development backs up to the Roebuck Road extension, said he and his members had worked to help the commission defeat the Callery-Judge Grove proposal for 10,000 homes west of The Acreage.
“You asked us, ‘please get people to oppose CalleryJudge,’” Greene said. “We worked hard to turn back that situation. I’m calling in my markers. I don’t want you to build that road.”
Earlier, County Engineer George Webb explained that the Seminole Pratt and Northlake improvements had been designed and would be implemented when the money becomes available. ITID Administrator Chris King complimented county staff on working with ITID staff to come up with the best solutions possible in trying economic times.
“My suggestion would be to go to the federal government and see if they can bail us out like they’re trying to bail everybody else out,” he said, noting that the ITID Board of Supervisors did not take a position on Roebuck Road, although residents opposed to it feel more people would benefit from Seminole Pratt Whitney Road improvements.
West Palm Beach Assistant City Administrator Eduardo























By Ron Bukley Town-Crier Staff Report
Despite objections from Fox Trail residents, the Palm Beach County Commission approved transmittal of a land-use amendment Wednesday that would allow a 160,000-square-foot mixed commercial and residential development at the intersection of Southern Blvd. and Seminole Pratt Whitney Road.
The property of about 64 acres is on the northwest corner of the intersection and borders the large-lot Fox Trail subdivision to the west. Wednesday’s vote sends the land-use change to Tallahassee for state review as a large-scale change to the county’s comprehensive plan.
Fox Trail Property Owners’ Association President Nancy Gribble told the commissioners that property owner Geoff Sluggett and another project representative had rejected her association’s compromise proposals, and that she would prefer the land-use designation remain agricultural-residential with a density of one unit per ten acres.
“We don’t want this commercial at this point,” Gribble said.
“It is premature.”
The association’s attorney Jane West said Sluggett had rejected proposals for both 200,000 and 160,000 square feet of commercial space, which is about what the applicant is currently requesting.
Other conditions proposed by Fox Trail included allowing permitted uses only, more buffering from the Fox Trail side and limiting operating hours to between 7 a.m. and 7 p.m.
“We put these two very reasonable proposals on the table,” West said. “Soundly rejected. No counter-offer, nothing. Just a sound rejection of these offers, so here we are today, and they’re going for everything. I really do think that a little more negotiation with the people who live there — your constituents — is reasonable here.”
West also argued that the developer was using the property’s inclusion in the county’s failed sector plan to justify the landuse change.
“That is improper,” she said.





“This land-use change must be able to stand independently on its own merit to comply and meet consistency with the comp
continued from page 1 year plan, saying that he and his staff had met with representatives of the South Florida Water Management District and the U.S. Army Corps of Engineers to raise concerns about Roebuck Road’s proximity to the West Palm Beach Water Catchment Area.
The city and the county struck a 1994 agreement that allowed the county to eventually extend Roebuck Road in return for the permitting of the Andros Isle, Baywinds and Riverwalk subdivisions, but attorney Luna Phillips, speaking on behalf of West Palm Beach, said that more recently a judge ruled that West Palm Beach could object to the project on environmental grounds.
“Now that the city is raising these environmental concerns, it should not be perceived as us reneging on the 1994 interlocal agreement,” Phillips said. “It’s in compliance with the more recent 2007 court order.”
Phillips also raised concerns about the extension’s cost, pointing out that the SFWMD recently stipulated that flyovers must be constructed in at least two locations for water flow rather than culverts as originally intended, which increased the cost significantly.
Webb said county and SFWMD officials have met to discuss Roebuck Road plans many times.
“Culverts are just big pipes under the road so the water can flow and the animals can move,” he said. “The district said that was an OK concept. We went forward and submitted those plans. They have since, with the urging of the residents and the City of West Palm Beach and others, said, ‘we would really prefer not to see a combination of fill and pipes. We think bridging, particularly on the westernmost north/south slough, would be appropriate.’” Loxahatchee Groves Coun-
plan as it currently exists.” County staff recommended approval of the amendment, saying that the developer had complied with all requested changes and conditions. County planner Sussan Gash said the developer had reduced floor area from an initial 280,000 square feet to 161,500, agreed to no single tenant of over 65,000 square feet, which would eliminate the possibility of a “big-box” retail store and keep the project in the scope of neighborhood service. The developer provided public green space, and of the 15 residential units on the property, three would be workforce housing, she said.
Gash added that the developer had done significant buffering, with two canals on the west side of the property adjacent to Fox Trail with a berm, six-foot wall and landscaping.
Indian Trail Improvement District President Mike Erickson, speaking as a resident because the ITID Board of Supervisors has not taken a position on the project, said he anticipates that an overlay for the area in place of the sector plan will designate that area for commercial just as the scrapped sector plan did.
“I believe this is the right site for some commercial,” Erickson said, pointing out that it is one of the few larger parcels under single ownership and that it is at a major intersection. Erickson said he felt the commercial center would actually alleviate some of the traffic problems in the area.
“Commercial redistributes traffic,” he said. “It doesn’t increase it.”
Commissioner Burt Aaronson agreed, saying a commercial center nearby will reduce traveling distance for shopping.
“People came up saying, ‘we don’t mind traveling six miles or 10 miles or 20 miles,’” Aaronson said. “That impacts on the roads, and having commercial closer means that people wouldn’t have to travel great distances to shop. People that say they don’t mind going six miles or 20 miles, number one, it’s not good for the environment and, number two, it impacts on the other communities around you. When you go to Welling-
cilman Dennis Lipp reiterated the town’s support of the Roebuck Road extension. “Roebuck has been on the books for 14 years,” Lipp said. “Traffic has increased. There are people who think the population is minimal. There are 50,000 people out there. I urge you to keep Roebuck Road.”
Commissioner Burt Aaronson noted the absence of officials from the Village of Royal Palm Beach and asked if they still support the Roebuck plans.
Webb said RPB still supports the road and added that studies showing the need for the extension have not changed. “Those traffic numbers are in line with what we expected 14 years ago,” he said. “I’ve told you before on the record and based on the current set of traffic counts, even with the eight-laning that we will have out there, when Okeechobee opens it will be over capacity. Roebuck provides relief to Okeechobee Blvd.” Commissioner Jess Santamaria said excessive development created the need for the Roebuck Road extension. “Over and over I see things I never saw in the ’70s and ’80s,” he said. “Those of you who are in Riverwalk, you live in zero-lot-line homes. I had never heard of zero-lotlines in the 70s. The smallest lots were 80-by-125-foot lots. But now you see postage stamp-size lots.”
Santamaria said all municipal officials in the county should be aware that development in other areas will affect them.
“You are here now to protect your little communities,” he said. “What happens in Boca Raton affects you. What happens in Royal Palm Beach and Wellington affects you. What happens in Palm Beach Gardens and Jupiter affects you. It’s not just Roebuck Road that will affect you. It’s everything that is happening all around that will affect you. If you don’t get involved, you ain’t seen nothing yet.”
Commissioner Karen Marcus made a motion to approve the five-year road plan, which was seconded
By Ron Bukley Town-Crier Staff Report
The Palm Beach County Commission agreed Tuesday to reimburse the Village of Wellington up to $150,000 for the installation of a traffic signal at the intersection of Forest Hill Blvd. and Quercus Lane.
County staff recommended approving the light, although studies showed that the light was unwarranted for that intersection, which is between Southern Blvd. and Wellington Trace, and serves as the only
entrance to part of the Pinewood East neighborhood.
The county money will partially fund the mast-arm signal, which will be installed by the village, according to the county staff report.
Although the county traffic division determined that the intersection did not warrant a traffic signal, the village sought it at the request of residents of Pinewood East, who said they were having trouble getting out of their development, according to the staff report.
Commissioner Jess Santamaria agreed to help fund the signal’s installation, contributing $50,000 from District 6 gas tax money to make a total of $150,000 coming from the county.
Last year, the village decided to take over control and maintenance of Forest Hill Blvd. from the county, giving the village the authority to install the signal.
The approximately $2,000 annual maintenance cost of the signal was a matter of some disagreement. The Wellington




Village Council did not want to accept maintenance responsibility for the signal, according to the county staff report, but the commission’s proposed approval of the funding contained a provision that Wellington bear those costs because the signal does not meet the county’s installation standards.
During the commission meeting, County Engineer George Webb asked for an amendment that the county and village would share maintenance.
“The county will be responsible for the signal controller box, and everything else at the intersection will be the responsibility of Wellington,” Webb
said. “That allows us to do appropriate tie-ins to other signals on either side.”
Commissioner Karen Marcus made a motion to approve the agreement, which was seconded by Commissioner Addie Greene. The motion passed 50 with commissioners Mary McCarty and Shelley Vana absent.













While the economic crisis continues to wash over the nation like a fiscal hurricane, South Floridians can rest a little easier knowing that last Sunday marked the end of the 2008 hurricane season. Indeed, the ever-looming threat that has hung over our heads like a guilty memory is no longer necessary. It is now safe to make weekend plans outdoors and put the storm shutters back in the attic. We are officially off the hook until next June.
Of course, this year’s lack of catastrophic hurricane activity in South Florida says more about our fortune than our level of preparedness. True, we made it through the season mostly unscathed, with the exception of Tropical Storm Fay, which ravaged parts of Wellington on its way upstate. Had that storm been stronger and aimed more directly toward us, chances are we’d still be dealing with the aftermath. Instead it brought sporadic flooding and spawned tornadoes over a limited area. Hurricane Gustav, Tropical Storm Hanna and Hurricane Ike blew by in a matter of just two weeks while we watched like an overconfident batter waiting to be walked to first base.
Being lucky is no substitute for being prepared — it’s a false sense of security. That is why we suggest not waiting until next summer to start getting ready. Besides putting up shutters and stocking up on supplies and food, one of the most important measures to
Editor’s note: The following letter is in response to Barbara Phillippi’s letter “Dog Park Rules Being Ignored” in last week’s Town-Crier
I have been going to the Wellington Dog Park for the past four years and have never seen the horrendous and life-threatening conditions that the letter writer complains about. I do take offense when she recklessly calls the owners of medium, large medium, small large and large (everything not small) irresponsible. What I find reckless and irresponsible is her behavior.
For the past eight months, we at the large dog park have watched the goings on in the small dog park with amusement. We have watched them take our benches and our garbage cans, but we just chuckled. We heard there were two people who were trying to instigate the rest of the small dog park. We were told that all the others do not like these two, do not agree with them and just want to have fun with their dogs. These are the same two who call the village every day to complain about something. At least now, one has stood up to be named. I feel that Ms. Phillippi’s own issues and problems are now escalating and that she should be put on a short leash. We all love the dog park, we all love our dogs — even though some of them are large — and we appreciate the village
giving us this space. If Ms. Phillippi likes Okeeheelee Park and finds no problems there, well, here we have the solution.
Jan Levy Wellington
This letter is in response to Barbara Phillippi and her cohorts in the small dog park (“Dog Park Rules Being Ignored,” published in last week’s Town-Crier). First of all, get a grip. The park was designed for the four-legged animals. It was not created as a social center for two-legged beings. When the newly improved dog park re-opened, [former Wellington engineer] Gary Clough held a meeting at the park for all to attend. He informed us of the Phase 2 plans that included gazebos, additional benches and a water play area for the dogs and people. The collective group thanked Mr. Clough and the village for the improvements, but requested that the village not go to the expense of gazebos, but please include additional benches, litter containers, and allow small pools for the pets to cool off in summer months. That has yet to happen.
We have four times the number of large dogs and people actively using the larger parks. We enjoy the privilege of having a park and take great efforts to keep it clean as well as be responsible pet owners. As a group, we do not allow aggressive behavior by any dog,
take before hurricane season is to have your home inspected. If cost is an issue, it doesn’t have to be. Private inspections may not cost an arm and a leg, but sometimes the thought of having to pay at all is enough to keep someone from making the call and setting up an inspection. Fortunately, there’s the My Safe Florida Home inspection program, which offers eligible homeowners free wind inspections by qualified hurricane mitigation inspectors. Homeowners who use the program stand a good chance of seeing a reduction in their windstorm insurance bills.
but we cannot be responsible for the bad behavior of some adults.
The small dog park has become a private club by some who attend there. A select few dictate who can enter and the size of the dog, including medium-sized dogs if the group approves of the human. One individual has told park guests that he bought the little dog park, and as owner he can do what he wants. They have commandeered the village maintenance crew to remove benches, trash cans and bag holders from the other parts of the park. They have constructed their own private patio by hauling in landscape bricks, and created a mosquito nuisance by covering the water decks with 20-plus water bowls. Each small dog must have his/her own private drinking bowl, so they declare.
Will the village be responsible when one of the senior citizens trips and falls on the groupconstructed patio? Should the village be held responsible for someone who has just had knee surgery and insists on attending?
As for aggressive dog ownership, smaller dogs are much more aggressive and active. Many of their owners encourage the larger dogs to run up and down the fence as a means of exercising their smaller animal. All is done with great spirit on both sides of the fence.
Please get a grip. Don’t allow a select few to ruin it for the majority of dog owners. We appreciate all the village has done in providing a safe environment for our animals, but let’s keep
in mind that it is for their benefit. It is not a human park. Linda Haughn Wellington
With reference to Mr. Tom Euell’s letter in last week’s Town-Crier, I think Mr. Euell should get over it and put his energies into something more productive and support our wonderful President-elect Barack Obama.
The Bush Administration and the Republican Party were an abysmal failure. They hijacked our economy, our banking system, our property markets, job markets, stock markets, insurance companies and credit card companies with no accountability to anyone due in part to a president who was oblivious to the shenanigans of his cabinet, which deregulated everything in sight — a free-for-all.
President-elect Obama is brilliant, not to mention a class act who will restore dignity to our White House and thus assure the world we are a country of laws and not a bunch of lawless Neanderthals who condone torture. Mr. Obama will also surround himself with brilliant minds who will jumpstart our economy, end the Iraq war, permit our great scientists to resume their multiple tasks (stem-cell research being one of them), and most importantly, monitor his advisors, unlike his predecessor, who allowed them to run amok. Subsequently we are in this horrendous economic meltdown. I don’t recall President Jimmy Carter’s America being in such sad turmoil, nor did he have the “mother of all attacks” (9/11) on his watch.
Welcome, President Obama. Godspeed.
Colette
Miller Wellington
of promises in order to get elected, and it is up to the American people to see that those promises are kept. Two areas in particular I will be watching closely are early education and early child care.
Scientists tell us that by age three, the human brain grows to about 80 percent of its adult size, 90 percent by age five. This window is a period of tremendous learning potential, but only if the child has the right educational resources. There is a critical shortage of early child-care centers, and funding for early child care was cut by $14 million in 2008. Children under four are not covered by the 2002 amendment that entitles four-year-olds to a year of free preschool. Not only that, space at day-care centers specializing in infant care is vanishing because providers can make more money taking care of older children who require less staffing per child.
Statewide, nearly 60,000 children are on waiting lists for subsidized child care, 6,500 of them in Palm Beach County. Of these, 60 percent are age four or younger, a threefold increase since 2003. In Palm Beach County, parents concerned about their children’s afterschool care miss an average of five extra days of work per year. This is estimated to cost employers anywhere from $500 to $2,000 per employee, per year. Currently, 8,914 children of working poor families are in subsidized child care with nearly as many on a waiting list; 2,200 of them have been waiting for up to two years.
funding for the Early Head Start program, increase funding for Head Start, and improve the quality of both. We should also soon see more federal funding for affordable high-quality child care to ease the burden on working families.
Obama has promised to reform No Child Left Behind, and throughout the campaign we heard the phrase “recruit, prepare, retain and reward America’s teachers.” I’d like to see the Palm Beach County School District actively pursue teacher service scholarships when they become available. These will pay for four years of undergraduate or two years of graduate teacher education, including highquality alternative programs for mid-career recruits, in exchange for teaching at least four years in a high-need field, such as bioscience. Let’s participate in voluntary national performance assessments to ensure that every new teacher is fully prepared to enter the classroom. New teacher residency programs are expected to supply 30,000 exceptionally well prepared recruits to high-need schools. Mentoring programs that match experienced teachers with new recruits will be expanded, and additional federal funds may be available to reward teachers who work in underserved places such as the Glades and some of our inner cities.
One of the largely unheralded items on any election ballot is the always stellar choices for local party officials. They are usually ignored by the media and often skipped over in the voting booth. That was the case, certainly, with young Derek Black, who managed to win a seat on the Palm Beach County Republican Executive Committee during August’s primary election. About the only time you even hear about one of those partisan positions is when you attend one of the committee’s meetings — the Democrats also have an executive committee — or when one of the delegates says, does or believes something so outlandish that it makes the news. Like Mr. Black, the 19-year-old son of a former Ku Klux Klan grand wizard, whom county Republican head honcho Sid Dinerstein has deemed not welcome as a GOP chieftain.
The technical reason Mr. Black is ineligible for the position is because he allegedly failed to sign a party loyalty oath before a June 20 deadline. Both parties require candidates to affirm that they will be loyal partisans in order to be eligible to serve on their respective county political executive committees. However, Mr. Dinerstein goes a step further by declaring that Mr. Black’s whitesupremacist views should be enough to make him persona non grata on the GOP committee.
By Don Brown

This drama may have played itself out by the time you read this. Mr. Black showed up at the executive committee on Wednesday to take his seat, which he was denied, along with a few others who failed to sign the oath. Mr. Black takes umbrage about the “white supremacist” label. Instead, he says, he is a white person who is concerned about discrimination against white people. And he has summoned a small posse of grand klansmen to help him — his father Don Black, a former KKK grand wizard, and David Duke, another former KKK grand wizard who also tried his best to go mainstream in Louisiana politics.
All of this leads me down memory lane — make that nightmare lane — to my days back in Louisiana and that state’s colorful political campaigns. I’ve met Mr. Duke more than once. He was a hand-

For homeowners who previously had been worried that home improvements would necessarily result in higher property taxes, Florida’s recently passed Amendment 3 prohibits the consideration of hurricane-resistant improvements and the installation of renewable energy devices in determining the assessed value of residential property. Making those upgrades won’t raise your taxes — they’re more likely to lower your insurance premium. With all the effort and time involved in purchasing a home, there’s no excuse for anyone to not make the extra effort to secure it every possible way they can. Although we lucked out this hurricane season, there are plenty more to come. Next June is closer than you may think. See LETTERS, page 5
As we welcome a new leader in Washington, there is a sense of renewed hope and excitement throughout our nation. A great deal is being expected of President-elect Barack Obama, and I think he will do well for us. Like any successful politician, Mr. Obama had to make a number
President-elect Obama’s comprehensive “zero to five” plan is aimed at providing critical support to young children and their parents. It places emphasis on early care and education for infants, which is essential for children to be ready to enter kindergarten. A new federal funding source, the Early Learning Challenge Grant, will be offered to promote “zero to five” efforts in Florida, hopefully accelerating a move toward voluntary, universal preschool. Obama has promised to quadruple federal
It’s clear our new president has some big challenges ahead, but I’m very optimistic that things will be better four years from now. As always, I welcome your comments and suggestions. Feel free to contact me or my staff at (561) 355-2202. Commissioner Jeff Koons, Chairman, Palm Beach County Commission Good Days At The Dog Park It was with great dismay I read the letter titled “Dog Park Rules Being Ignored.” Quite to the contrary, I have found the town most responsive to my only request, which was to spray
The Town-Crier welcomes letters to the editor. Please keep letters brief (300 words). Submit letters, with contact name, address, and telephone number (anonymous letters will not be published), to The Town-Crier, 12794 W. Forest Hill Blvd., Suite 31, Wellington, FL 33414; fax them to 793-6090; or you can e-mail to letters@ goTownCrier.com.
some (after a few nips and tucks here and there) young up-and-coming political figure living in the New Orleans suburb of Metairie in Jefferson Parish in 1989 when he won a seat in the Louisiana House of Representatives. At the time, he denied persistent rumors that he was a klansman, perhaps most likely because he had already formed another organization that also didn’t like AfricanAmericans or Jews. I don’t recall ever meeting Don Black, but I had heard his name.
Before and after his one and only election to the Louisiana House, Mr. Duke ran numerous unsuccessful campaigns for president, governor, the state senate, the state house and both houses of Congress. He ran all of those campaigns attempting to exploit a racial divide at the time.
However, as a student of politics, my favorite campaign was Mr. Duke’s run against Edwin Edwards in 1991. Mr. Edwards, a former U.S. congressman, served a total of 16 years as a populist Louisiana governor, but not sequentially due to the state’s eight-year limit. Mr. Duke ran against him when he was between governorships, and while he enjoyed popularity among the state’s large African-American population, his overall appeal was on the decline amid allegations of corruption. Mr. Edwards was regarded as an underdog in the campaign.
Mr. Edwards enlisted his pals all over the state to help him despite repeated accusations of corruption. They responded with bumper stickers that read “vote for the lizard, not the wizard.” Other bumper stickers soon showed up such as “vote for the crook. It’s important,” and “he may be a crook, but he’s my crook.” When asked what he needed to do to defeat Mr. Duke, he replied, “stay alive.”
But my favorite quote by Mr. Edwards, who is currently serving a federal prison sentence for criminal charges while out of office and who is hoping President George W. Bush might yet pardon him, is this one delivered to 60 Minutes during that campaign against Mr. Duke. With absolute confidence, he said, “the only way I can lose this election is if I’m caught in bed with either a dead girl or a live boy,” a comment he had made during previous campaigns.
Florida’s politics is rough enough without bringing Louisiana politics into the mix. My own sons would have phoned in a minor problem. I’m wondering why Mr. Black required a personal visit from his father and the other former grand wizard, Mr. Duke, to help bail him out of his own rather insignificant mess. Perhaps he is the victim of his own youthfulness and lack of knowledge of our political system.
Viso LASIK Medspas in Wellington teamed up with the Guide Dog Foundation for the Blind on Tuesday for a day of beauty. The event featured hors d’oeuvres and cocktails, as well as special discounts on beauty services, with ten percent of all sales for the day donated to the foundation. Viso LASIK Medspas is located at 2515 State Road 7, Suite 210. For more info., call (561) 795-4772 or visit www.visolasikmed spas.com. For more information about the Guide Dog Foundation for the Blind, visit www.guidedog.org.
PHOTOS BY DENISE FLEISCHMAN/TOWN-CRIER

continued from page 4 the fields, since all the rain had caused an infestation of mosquitoes. It was done the next day. I feel the big dog owners are being pitted against the small dog owners. I was thrilled when Wellington opened the park. The dog I had at the time was Sugar, a pound dog. She just liked to visit and watch all the other dogs. She was somewhat of a couch potato but enjoyed the action. She thrived in the center park, which was originally intended for frail and senior dogs. Bayleigh, on the other hand, is a rambunctious 50-pound “Heinz 57” rescued from the pound, just as many of her other big dog park playmates (few are pedigreed). Her main joy in life is going to the park. I agree — dogs should be leashed to access and egress the park. We are all animal lovers, and would hate to see an accident. People can make honest mistakes and not see feces. Be so kind to point it out to them. Sometimes dogs dig holes to cool themselves, especially in the heat. Give us tools to fill them. The big dogs also loved the small swimming pools (supplied by the pet owners). They were used to cool the canines off
from the Florida heat. These pools were recently removed by the village. I would like us to get back to those early days when the park opened, and we were delighted to have a place for our pets and to be away from the melee of Okeeheelee. All owners of big, small, feeble and frail dogs, had great grins, as did the dogs. We all greeted each other and spoke to strangers. And on one of those first days, a gentleman said to me, “ah yes, it’s always a good day at the dog park.” So let it be once more.
Marjory Mount Hulin Wellington
Editor’s note: The following letter is in response to last week’s letter “Reasons For Not Supporting Barack Obama” by Tom Euell, which responded to Andrew Rosen’s letter “Many Reasons To Support Barack Obama.”
First, Mr. Euell, let me say your personal attacks are unnecessary, childish and not really relevant to an adult discussion of the issues. Second, due to


space considerations, I will respond to only a few of your comments. And third, it is obvious that you have missed my point on so many issues, so I will re-explain some of them. You say you would like to see my degree in science and the English language concerning the usage of the word “theory” when defining evolution. You are free to come to my house and see my science degrees. I have no English degree, but have published in three countries. The word “theory” is used differently in lay terms than it is in science. In lay usage it means an idea, a hypothesis, a speculation. In science it is considered “a statement of what are held to be the general laws, principles or causes of something known or observed” (Oxford English Dictionary). In science, a theory is made up of facts. Please also note that I believe in the Gravitational Theory and the Theory of Relativity. I agree with Mr. Euell that Jimmy Carter was an ineffectual president, but most experts will agree that the economic times we are going through and about to go through are the worst since the Great Depression. Luckily, some systems are in place to help people and possi-
bly mitigate some of the disastrous effects of that time, and we can hope the bread lines of then won’t happen now.
I also do not blame George W. Bush for 9/11 — I blame the terrorists. And yes, his information was faulty, and he could not have stopped it. For that I do blame the Clinton Administration. They could have gotten Osama Bin Laden when he was on the most wanted list before 9/11. And I do not think it was inappropriate to go to war in Afghanistan. I also agree that we have not experienced another terror attack like 9/11. What Mr. Euell fails to realize, however, is that the job in Afghanistan was not really well done and there was no reason to go into Iraq. (Al Qaeda was not in Iraq nor was Iraq involved in 9/11). And whether he thinks so or not, some personal freedoms have been infringed upon. When one curtails the personal freedoms of any group, it affects everybody. And if Mr. Euell truly believes that monitoring calls of suspect individuals was the only outcome of the Patriot Act, then he should look into it further.
Mr. Euell also misinterprets strength for being a bully when discussing Mr. Bush and his administration. Nobody says this

country should sit back and take things in a Neville Chamberlain, pre-World War II appeasement way. But if one objectively looks back at this administration, which will go down in history as one of the worst, they will see that bullying is the appropriate word to use.
I also do not sit by and leave the Democrats blameless for this current economic state of affairs (see my letter in the Nov. 21 issue). It is both parties’ fault, but the Republicans have been running this country for eight years, and it is illogical not to put the majority of the blame on them. Yes, the Democrats have had control of the House and Senate for the past two years, but the Republicans had that control and the White House for the previous six years. There is much more to Mr. Euell’s article that deserves comment, but I will simply reply to two more things he wrote. He stated, “it’s too bad you hate your country, Mr. Rosen.” I take offense to this, and he could not be more wrong. He misunderstands disagreeing with the government, even in a vehement way, with hating one’s country. This is not true, and if he thinks exercising freedom of speech
as hatred, then he misunderstands many things about America. I do not say that Republicans hate this country because of their views, and Mr. Euell should rethink that comment. The final item I will take issue with is Euell’s comment that he will fight anyone who tries to “socialize” [America]. This line about Mr. Obama being a “socialist” was thrown around as a scare tactic during this election. Does Mr. Euell even know what socialism is? He says he is older then I am (I am 51 years old), so I am wondering if Mr. Euell gets Social Security? Medicare/Medicaid? Are these not socialist programs? They were called that when they were started, but no Republican would try to take them away. Was Mr. Euell part of any union during his lifetime? Could that not be construed as a socialist program? In closing, Mr. Euell, I refer you to my previous letter and ask that you stop this knee-jerk reaction and try to understand what Mr. Obama’s policies are, and try to support him. After all, he is the president-elect of all of us.
Andrew Rosen Wellington















By Jason Budjinski Town-Crier Staff Report
NOV. 30 — An employee of the BJ’s Wholesale Club in Royal Palm Beach was arrested last Sunday on a grand theft charge. According to a Palm Beach County Sheriff’s Office report, 25-year-old Sara Weiss of Wellington had been pocketing the cash back from debit purchases. According to the report, after customers entered their card’s PIN, Weiss would turn the machine around and press the “yes” button for cash back, taking $100. When the customers inquired about the cash, BJ’s reimbursed them and discovered that Weiss was the cashier each time. This led to an investigation and Weiss’ subsequent arrest. She did this three times altogether. Weiss confessed and was taken to the Palm Beach County Jail.
• • •
NOV. 29 — A deputy from the PBSO substation in Wellington responded to a home on Dorchester Place last Saturday morning regarding a residential burglary. According to a PBSO report, the victim and his family were away on a cruise from 11:30 a.m. Nov. 22 to 11 a.m. last Saturday. When they returned, they discovered their house had been burglarized. Stolen from inside was an HP Pavilion laptop computer, a 26” LCD Sharp television, a 36” LCD Sharp television, an older 20” LCD television and a few watches. The front door was found open and many of the lights were left on. A white van was seen parked in the driveway of the abandoned house next door. There were no witnesses or other information available at the time of the report.

NOV. 29 — An employee of the TJ Maxx store on State Road 7 called the PBSO substation in Royal Palm Beach last Saturday regarding a grand theft. According to a PBSO report, the employee observed 18-year-old Mikeria King of West Palm Beach and 19-year-old Denisha Camble of Wellington select 43 miscellaneous clothing and baby items and conceal them in three separate bags. They then fled the area in a 1993 Toyota Corolla but were stopped by PBSO deputies at the intersection of SR 7 and Southern Blvd. They were identified by a store loss prevention officer. The stolen items, which totaled $463.03, were recovered. A background check revealed there was an active warrant for Camble’s arrest for violating parole. King was issued a citation for driving without a license. Both were arrested and taken to the county jail.
NOV. 29 — A deputy from the PBSO substation in Wellington was dispatched to the Wellington Community Center last Saturday night in response to a vehicle burglary. According to a PBSO report, sometime between 4:30 and 9:45 p.m. someone shattered the front passenger window of a Ford Explorer that was parked in the community center’s parking lot. Stolen from inside was a purse containing multiple credit and debit cards. There were no witnesses




or suspect information at the time of the report.
DEC. 1 — A deputy from the PBSO substation in Wellington was dispatched to a parking lot in the Wellington Plaza Monday in reference to a vehicle burglary. According to a PBSO report, the victim parked her vehicle and entered a business at approximately 3 p.m. When she returned at approximately 4:10 p.m., the victim discovered someone had entered her vehicle and stolen her purse, which contained a cashier’s check in the amount of $1,695, $80 cash, a driver’s license and multiple credit cards. The hatch door had been left unlocked, which was the point of entry, according to the report.
DEC. 2 — A Greenacres woman was arrested Tuesday night for shoplifting at the Bealls department store in Royal Palm Beach. According to a PBSO report, a store employee observed 19-year-old Rosalinda Avelez select a pair of earrings from the jewelry department, take them out of their package and conceal them in her left front pocket. Avelez then exited the store without paying for the merchandise and was apprehended by store security. She was arrested, charged with retail theft and taken to the county jail.
DEC. 2 — A resident of Bayview Drive called the PBSO substation in Wellington on Tuesday regarding a home burglary. According to a PBSO report, sometime between 10:30 a.m. and 1:30 p.m. someone gained entry to her home and stole a 55” flat-screen television and laptop computer from the family room area. Other stolen items included two Visio flat screens, an iPhone, a Sony digital camcorder, a Nikon camera and several iPods. While examining the exterior of the residence the deputy discovered pry marks on the rear sliding door. DNA was processed and placed into evidence.
DEC. 2 — An Acreage man was arrested Tuesday night for driving drunk in Royal Palm Beach. According to a PBSO report, a deputy from the Royal Palm Beach substation was dispatched to a pub on Okeechobee Blvd., where he made contact with 58-year-old Cleo Sylvain. Sylvain was about to drive away in his pickup truck when the deputy arrived. Sylvain’s vehicle nearly struck the officer’s, according to the report. The deputy asked Sylvain to exit his vehicle and perform roadside sobriety tests. He was taken to the blood alcohol testing facility, where he refused to submit to a breath test.
DEC. 3 — A deputy from the PBSO substation in Wellington responded Wednesday to Dorchester Park regarding a vandalism incident. According to a PBSO report, a witness observed three white male juveniles near a plastic bench at the park at approximately 7 p.m. One of the juveniles set the bench on fire. The witness could recall only one of the suspects, whom he described as between 5’10” and 6’ and having a thin See BLOTTER, page 9

Crime Stoppers of Palm Beach County is asking for the public’s help in finding these wanted fugitives:
• Alisha Mojica is a white female, 5’3” tall and weighing 215 lbs., with brown hair and brown eyes. Her date of birth is 06/23/85. Mojica is wanted for failure to appear in court on the felony charge of grand theft and the misdemeanor charges of no, improper or expired driver’s license and obstruction by disguise. Her occupation is unknown. Her last known addresses were Abbey Drive in Greenacres and Seaford Drive in Wellington. Mojica is wanted as of 12/ 04/08.
• Basil Sharif is a black male, 6’ tall and weighing 160 lbs., with black hair and brown eyes. His date of birth is 02/ 16/85. Sharif is wanted on the felony charge of lewd or lascivious battery. His occupation is nurse. His last known address was Stonegate Drive in Wellington. Sharif is wanted as of 12/04/08. Remain anonymous and you may be eligible for up to a $1,000 reward. Call Crime Stoppers at (800) 458-TIPS (8477) or visit www.crimestopperspbc. com.



Bobby Maher and his family have grown Christmas trees on their North Carolina farm for more than 30 years, but the closest he was ever able to bring them to his neighbors in The Acreage were at Christmas tree lots in Broward County.
That changed last year when a partnership of three Acreage families found a way to put a Christmas tree lot in The Acreage. Robert Trepp and Sofia Rossi of Tromsi Inc., the same people who organized the Acreage Music & Chili Festival last spring and the Acreage Fall Festival last month, persuaded commercial property owners on Seminole Pratt Whitney Road to allow the tree lot. Now it sits in front of the Grove Marketplace.
“The only place you can have a tree lot is on commercial property,” Trepp said. “Well, we don’t have much of that in The Acreage. But this is something good for the community, so we worked hard to help make it happen.”
You’ll find Lisa Goodhead at the lot all Christmas season, accompanied by her husband Jamie after his regular work hours. The pair has been selling Christmas trees in other lots that the Mahers operated for the past

12 years, Lisa said. Last year, they were able to work close to home for the first time.
The partners have incorporated the community into the tree lot. Area students work there, and a portion of sales will benefit the New Beginnings Educational Foundation, which was established to provide assistance to teens and young adults in the western communities in completing high school, technical school or college.
This year, the Acreage Christmas Tree Lot has partnered with Adopt-A-Family of the Palm Beaches to bring a little joy to needy families. The partners are asking families to bring an unwrapped new or like-new toy to be placed under a big tree on the lot. All the toys will be donated to Adopt-A-Family.
The decorations on the tree come from the community as well. Area children are bringing in handmade decorations to hang on the Adopt-A-Family tree. In exchange, their family receives a five-percent discount on the price of a tree. Trees are fresh-cut no more than four days before delivery to the lot, and range in size from five to 12 feet tall. The lot will be open until Dec. 24.
The grand opening of the new Wellington High School Performing Arts Theater will be held on Thursday, Dec. 11 at 7 p.m. The performance will feature the WHS chorus and band programs in their annual winter concert. The program will feature traditional choral and band music as well as holiday favorites. A dessert reception hosted by the WHS chorus and band booster associations will follow the concert in the cafeteria. Admission is free.
Moksha Yoga Studio (3340 Fairlane Farms Road, Suite 5, Wellington) will feature Thai yoga bodywork training Dec. 57. Learn choreographed body work sequences synthesizing rhythmic compressions, stretching, ancient breathing arts, acupressure and meditation to produce profound rest and rejuvenation. Study a 3,000-year-old traditional Southeast Asian folk art that creates inspired tranquility and health. Experience simple procedures to assist in rapidly eliminating disease both physical and emotional. The
cost to attend is $350. For more information, call (561) 4271767.
The Loxahatchee Groves Landowners’ Association will meet Thursday, Dec. 18 at 7 p.m. inside Classroom 1 at Palms West Hospital. The guest speaker will be Fred Rapach of the Palm Beach County Water Utilities Department. He will discuss Everglades restoration and what effect the project will have on the Groves community. For more information, contact Marge Herzog at (561) 791-9875 or marge@herzog.ms.
The Good Earth Farm (2141 B Road, Loxahatchee Groves) will host a hands-on introduction to equine-assisted therapy Friday, Dec. 19 from 9:30 a.m. to 12:30 p.m. This is a hands-on and fun way to learn about equine-assisted therapy and how people gain selfawareness and self-knowledge by engaging in activities with horses. No horse experience is necessary. Pre-registration is required. Call (561) 791-8939 for more information.


























The Wanderers Club at Wellington kicked off the holiday season by hosting the inaugural Wellington Village Golf Tournament, and it was a huge success, said Director Justin Thompson.
“The golfers had a lot of fun, they all enjoyed playing the
course, and the competition was pretty fierce,” Thompson said. “The course was in excellent shape. We enjoy being a part of the community, and this is one of the ways the Wanderers Club gives back.”
The winning foursome of

Bart Arnold, Todd Baker, Sgt. Ole Olson and Mark Strong shot a net 61 and earned first place on a match of cards. Finishing second was the team of Myles Tashman, Richard Desich, Don Dufresne and Steve Pollard, also with a 61. Mike Gauger, Louis Lamm, Bruce Hannan and Dale Hesser combined for a 62 and placed third, which also was determined by a match of cards.
Ron Mattino won the closest to the pin contest, landing four feet, eight inches from the hole on number 5, a 148-yard, parthree. Chris Grubb won the longest-drive contest on number 12. Nine foursomes representing Wanderers Club members, the Village of Wellington, the Palm Beach County Sheriff’s Office, Palm Beach Fire-Rescue and local businessmen participated in the event.
Wanderers Club Operations
President John Wash said he was very happy with the experience
The Jewish Community Center of the Greater Palm Beaches is holding the 19th Annual Palm Beach Jewish Film Festival Dec. 3-14. Some of the films will be screened at the Wellington Reel World Cinema 8 (13881 Wellington Trace, next to the JCC Wellington branch in the Wellington Marketplace). International in scope with 36 films from a dozen countries, this year’s themes, among others, include explorations of the traditions, rituals and lives of Sephardic Jews from North Africa, the trials and tribulations of becoming a bar/bat mitzvah, and the lingering affects of the Holocaust on survivors and their families.
The Wellington film descriptions and schedule are as follows:
• Two Lives Plus One , Thursday, Dec. 11, 7:20 p.m.
— Directed by Idit Cebula, this 2007 French film is about Eliane Weiss, a woman dedicated to her husband, daughter, widowed mother and students. But Eliane longs for more. When she starts working on her passion, writing,
and meets an attractive publisher who’s interested in publishing her work, everyone is taken by surprise. It’s a charming comedy about one woman’s explorations of herself, her family, and the Jewish heritage that binds them. Shown with English subtitles.
• Let’s Dance , Saturday, Dec. 13, 7:20 p.m. — Also from France, this film by director Noemi Lvovsky focuses on Salamon Bellinsky, a Holocaust survivor who knows the end of his life is near. But he knows just as well it hasn’t arrived yet. Salamon throws himself into tapdancing lessons, seeks a companion to sweeten his golden years, and lives life to the brim. One of the most original films about older characters seen in ages. Shown with English subtitles.
• Emotional Arithmetic , Sunday, Dec. 14, 3:15 p.m. — Canadian director Paolo Barzman’s drama stars Susan Sarandon, Gabriel Byrne, Christopher Plummer and Max von Sydow. The film looks at friends who meet decades after their release from Drancy, a transit camp out-

side of Paris during WWII. Memories and long-suppressed love re-kindle. Similar to last year’s Fugitive Pieces, the focus is on how the past affects the present.
All programs are subject to change without prior notice. Most films are unrated; some may contain adult content.
A complete description of all films, the film schedule and information about purchasing festival passes or individual tickets can found on the PBJFF web site at www.pbjff.org. For more information about the 19th Annual PBJFF, call (561) 7125201.
The Jewish Community Center of the Greater Palm Beaches strengthens and enriches Jewish families, individuals and the community at large through excellent cultural, health, educational, and social programs and services that emphasize Jewish values, build Jewish identity, and create deeper connections with the community, enhancing the quality of life for all. For more information, visit www.jcconline.com.
shared by all at the event. “Wellington has such a strong sense of community, and the golfers who participated are an integral part of that fabric,” Wash said. “This tournament was about friendly competition and building new friendships. Everyone had fun, the golf was competitive and spirited, and the winners have bragging rights until next time.”
The Wanderers Club at Wellington is an invitation-only private club. It recently underwent a multi-million-dollar renovation of the golf course by the Jacobsen Hardy Design Group. The golf course features waste bunkers, a new irrigation system, replanted Tifway 419 fairways and roughs, TifEagle greens, plus two short-game practice areas and a driving range that converts into a polo field. For more information about the Wanderers Club, call (561) 795-3510.

After careful consideration, the California Center for Advanced Dental Studies has announced that local dentist Dr. Farokh Jiveh has been appointed as a mentor-senior instructor.
“We are thrilled to have Dr. Jiveh as a mentor-senior instructor,” CCADS Program Director Dr. Thomas Dudney said. “He absolutely possesses all the qualities we look for. He’s a premier clinician and an outstanding teacher.”
Dr. Jiveh’s selection is the result of a rigorous process that includes an in-depth look at the doctor’s collegiate and postgraduate education, clinical skills and overall integrity. In order to be selected, the dentist must have completed a minimum of 120 hours and three levels of advanced clinical training from accredited postgraduate programs.
“What distinguishes our mentors is their comprehension and use of advanced clinical protocols for veneers, including all types of indirect all-ceramic and ceromer composite restorations, and their overall commitment to excellence in their practices,” CCADS President Garrett Caldwell said.
CCADS mentor-instructors
have many responsibilities, including conducting their own local study groups in their offices and instructing nationally and internationally at seminars and live patient hands-on programs. However, more important than their clinical duties is their responsibility to the public and to any doctor who seeks assistance or mentoring in the field of cosmetic dentistry.

has completed hundreds of hours of advanced postgraduate education in the field of cosmetic dentistry, including finishing master’s level at the Aesthetic Advantage Live Patient Hands-on Continuum.
Dr. Jiveh maintains a private practice at 11989 Southern Blvd. in the
Dr. Jiveh is recognized in his community as a leader in cosmetic dentistry. He graduated among the top of his class from
continued from page 6 build and goatee, and wearing a black knit cap, light-colored tshirt and blue jeans. The suspects left the area in an unknown direction. The case is inactive pending further leads.
(561)
DEC. 3 — A Minnesota man was arrested Wednesday for shoplifting at the SuperTarget store on Okeechobee Blvd. in Royal Palm Beach. According to a PBSO report, 21-year-old Jose Escorcia-Maroane was observed taking two Blu-ray DVDs and concealing them inside his sweater. Escorcia-Maroane then exited the store, passing all points of sale. He was apprehended and taken to the store security office, where the merchandise was recovered. Escorcia-Maroane was charged with petit theft and taken to the county jail.
















By Carol Porter Town-Crier Staff Report
Relations with the Loxahatchee Groves Water Control District figured heavily in discussions at the Loxahatchee Groves Town Council meeting
Tuesday. While the council approved a list of topics for discussion by a joint town-district committee, one council member forced an unsuccessful vote on requesting that the state legislature make the district a dependent entity.
That motion was apparently made in response to news that objections made by the LGWCD figured heavily in the state’s review of the town’s comprehensive plan, which was completed and submitted in September.
On the same date the council approved sending the comp plan to Tallahassee, it also chose a consultant to produce a study on the feasibility of making the LGWCD a dependent district or abolishing it.
In October, the consultant recommended against such action, suggesting the town and district instead form a joint committee to resolve problems between the two entities, most of which center on control of funding for road maintenance work. Last month, the council named Vice Mayor Marge Herzog as its representative on the committee.
On Tuesday, the council approved a list of topics to figure in the coordination committee’s first meeting, as yet unscheduled. The list included road and
continued from page 2 ton, it impacts on the travel in Wellington.”
Aaronson said he agreed with the applicant’s reason for rejecting the Fox Trail proposals, that 7 p.m. is not a reasonable closing time for a commercial center. “Seven in the evening to close is not convenient for a shopping center,” he said.
Developer’s agent Bob Bentz said he had pointed out to Fox Trail representatives that the application already complied
maintenance responsibilities and jurisdictions; coordination relating to the town’s comprehensive plan; coordination with the town for road improvements; and the district’s 2009 permit variance from the South Florida Water Management District on required canal levels.
Councilman Dr. Bill Louda said his biggest concern is getting town and district representatives to work together.
“I would hope the district would rescind all objections to the comprehensive plan,” he said. “This is an absolute first priority. If this doesn’t occur, us getting together on road maintenance issues is moot.”
Herzog concurred and said a continued lack of cooperation could jeopardize some funding.
“If we can’t get the issue about road maintenance resolved, we are going to be in trouble with our gas tax money and with allocation,” she said. “If we can’t clear up that issue, it will be a big problem tax-wise.”
Herzog added that she was not convinced that the district wants to take part in joint meetings and asked what would happen if that were indeed the case.
E Road resident Howard Voren said he hoped both sides could cooperate to work out their issues, but also said he was concerned that town staff had not verified the signatures on road stabilization petitions collected by the district.
“You owe it to the citizenry of this town to check what the Loxahatchee Groves Water
with most of their demands, including square footage, buffering and shielded lighting to reduce night glow, but the 7 p.m. closing is not reasonable.
“We have a restaurant there, and no restaurant is going to be successful if it closes at 7 p.m.,” Bentz said. “Additionally, one of the tenants is a grocery store, and they are open typically till 9, 10 or 11 o’clock at night… We have had several meetings in good faith and addressed key issues. I think we have gone above and beyond.”
“I agree,” Aaronson said, adding that the grocery stores in his neighborhood close at 9 p.m. and the buffering with the two
Control District has done for the surveys, whether they were done legally or were done in a hodgepodge like the last time,” Voren said.
LGWCD Supervisor Ron Jarriel said the town had enough on its plate without worrying about the district’s responsibilities, but invited council members to come to the district’s Dec. 8 meeting if they wanted further proof of the authenticity of the signatures.
“If you want to see what the percentages are, they will vote yes or no,” Jarriel said. “That will save a lot of research. You will hear our responsibility Monday night if you come to our meeting.”
Councilman Dave Autrey made a motion to approve the list of items for the intergovernmental committee, which was seconded by Louda.
Resident Ken Johnson asked if the meeting would be open to the public, and Town Attorney David Tolces said it would be, but public comment would not be allowed. The motion passed unanimously.
Moving on to the state’s review of the town’s draft comprehensive plan, consultant Shelley Eichner told the council the Florida Department of Community Affairs had issued a report listing 26 objections including issues such as housing stock, roads and rights of way.
Eichner, whose firm Calvin, Giordano & Associates had prepared the comp plan, said that while most objections could be
canals and the land is about 350 feet.
Bentz said the developer prefers to retain the option of conditional uses, and that a restaurant or a daycare center would be preferred options.
“There are other good uses we should be allowed to do,” he said.
Commissioner Jess Santamaria said that he agreed with West’s argument that each application should be based on its own merit. He said when he met with Sluggett and Bentz initially, the application was unacceptable.
“I vehemently opposed the intensity,” he said. “It was over
addressed by a phone conversation, some would require more effort, and that some objections she had never seen before in such a report. She was confident that the issues could be resolved within the 120 days required for a response.
Eichner added that the DCA had given great consideration to the issues raised by the LGWCD, and those objections need some resolution.
“It needs to be decided who has control over what roads,” she said. “What the level of service is. The letter the district sent to the DCA, the DCA gave it a lot of weight.”
Mayor David Browning suggested that Eichner contact the DCA planner who reviewed the town’s comprehensive plan.
Louda made a motion that the town’s planning staff do whatever necessary to resolve the issues raised by the DCA, including possibly sending their own planners to Tallahassee. The motion was seconded by Councilman Dennis Lipp and passed unanimously.
Herzog again said she feared the town was chasing its tail and asked what would happen if the two sides could not resolve their differences in 120 days. “You have three years to adopt a comprehensive plan,” Eichner replied. “You could not process the future land-use initiatives. You could not use funding.”
Herzog said residents are being held hostage in such a situation. Autrey added that he was worried as well, and it seemed
280,000 square feet. I said there was no way I would support it.”
Santamaria said the application was made more palatable by the buffering, berming and separation, and density reduction.
“I definitely emphasize the importance of being sensitive to the residents of Fox Trail,” he said. “We are going to be watching the buffering through every step of the application. On the other hand, the residents of The Acreage have been very supportive.”
Santamaria made a motion to approve the amendment, which was seconded by Aaronson. It passed 6-0 with Commissioner Mary McCarty absent.








that the district had created a list of objections that the town could not satisfy. “Doing nothing is not an option,” Autrey said. “I am trying to think through what we are doing if none of this will work. We are risking the ability to process land-use plans, [use] state revenues and a lot of other things. We are back to square one to resolve it.”
Autrey made a motion to request the state legislature make the district a dependent of the town, which was seconded by Herzog.
Lipp said he could not support the motion when efforts were being made to get the two sides to start working together.
“I think it’s foolhardy to do that,” he said. “We decided tonight what items we should talk about. I see this, and I think it stinks. It’s just some insider politics going on, and it doesn’t sit right with me.”
Louda would not support the motion either. Although he favors a dependent district, rushing the process would divide residents. “The district has to eventually become the town’s public works department, but when we are an adolescent,” he said. “We’re not there yet. We went too fast. It’s splitting the town right down the middle.”
During public comment, resident Frank Schiola said the district now bears the burden of cooperation. “We know now how it is,” he said. “This gives a reason to cooperate. If the district does not step up to the plate, the people will be behind you, and make the district do it. The outcry will be too much.”
Autrey, however, stood by his motion. Sensing a lack of votes in favor, he said he hoped it would work out. “If you want to roll the dice, that’s fine,” he said. “We have 120 days.” The motion failed 3-2 for the district to be dependent, with Autrey and Herzog in support. Lipp then made a motion to remove Herzog from the joint committee to be replaced by Browning, but it died for lack of a second.
Both Lipp and Browning stressed the necessity for cooperation. “We have 120 days to work together,” Browning said. “We have to work together. That’s the bottom line.”
During council comments at the end of the meeting, Autrey noted that he would not be running for re-election to the council next year due to a medical condition. “A year ago I found out I have cancer,” he said. “I have made a decision I will not run in March due to health reasons. I will strongly support Ilene Rindom for Seat 1 this March.”
Browning also said he would not support the motion. He compared it to kids swatting at a hornet’s nest to see what would come out. “We talk about cooperation,” Browning said. “Then we take a shot at the water control district after promising to work together. Every time we turn around, we are trying to put through some legislation that will dissolve them.”
Grand opening festivities will be held Sunday, Dec. 14 at Fine Art at West Best in West Palm Beach. The gallery, which is operating in conjunction with the adjoining West Best Jewelers, is owned by artist Ursula Fernandez and is located at 2602 S. Dixie Highway. The grand opening will take place from 4 to 7 p.m. and feature artwork by Fernandez and Judy “Yudit” Eisinger. Born in Havana, Cuba, Fernandez began painting and sketching at age 15. She paints in oil, and much of her success has been in still-life paintings and portraiture. Fernandez is a recognized member of the Wellington Art Society and has had many successful exhibits. Eisinger was born in Budapest, Hungary, and emigrated to the U.S., where she began painting at an early age. Her mixed-media paintings have earned her numerous regional and national awards over the past 30 years. For more information, call Fernandez at (561) 301-6848.















By Don Brown Town-Crier Staff Report
Planning for the American Cancer Society’s 2009 Acreage/ Loxahatchee Relay for Life kicked off Monday, Nov. 24 with a fun celebrity bartending fundraiser held at Kocomo’s Island Grill in The Acreage. This year’s relay will be held April 17-18 at Acreage Community Park, event chair Michelle Damone said.
“I want to thank everyone who participated or came out for the ACS kickoff party,” said Damone, also an Indian Trail Improvement District supervisor.
Kocomo’s Manager JoAnn Bouthillier invited the committee to host the event at the popular local eatery where Damone
and fellow ITID Supervisor Carol Jacobs served as bartenders to raise funds to fight cancer.
One of Kocomo’s regular bartenders, Randy Valcana, clocked in for work that night on behalf of Relay for Life, giving up his own $250 in tips for the organization. Valcana’s father recently died of cancer. Jacobs is serving as sponsor chair, and ITID Supervisor Ralph Bair is serving as the district’s team chair. This year’s theme is the “Wonderful Year of Disney.”
Michelle Cavanaugh of the American Cancer Society, Damone’s daughter Marissa and Jacobs’ daughter Lindsey modeled the restaurant in the Disney theme, with princesses decorating the walls and big Mickey
Mouse ears everywhere. Connie Christman and her Luminary Committee brought along a pop-up tent, a 1955 Chevy dressed up as a luminary with lighted bags. Robert Trepp brought along the Chili Chicks, who kicked up their heels, as well as local band the Electric Hearts, who provided the entertainment.
With three more teams signed up at the kickoff, seven teams have now been formed, all to raise money for a good cause. American Cancer Society Associate Director Nicole Jablonski said the Acreage/Loxahatchee Relay for Life has become the model for Relay for Live events throughout Palm Beach County.

Science Smarts — Dream Middle School students show their awards for placing in the Nov. 13 science fair.
Ideal Elementary School and Dream Middle School’s Science Fair was held on Nov. 13. Kindergarten through fifth-grade students submitted class projects while students in grades six through eight submitted individual projects to the school-wide science fair. Science projects were evaluated on each student’s oral presentation and display. Judges for the science fair were Scripps Research Institute Vice President of Scientific Operations Dr. Harry Orf, Scripps Education Outreach Administrator Deborah Leach-Scampavia and Scripps graduate student Luis Tuesta.
Eighth-grade student Jennifer Mezzetti was chosen as the overall science fair winner for her project “What Germs Are in a School Setting?”
Twenty-one students will advance to Palm Beach County’s District Science Fair. Ribbons
were awarded to the following Dream Middle School students: Mezzetti, first place in eighth grade and overall fair winner; Morgan Pica, second place in eighth grade; Cameron Wheeler and Michelle Marchand, tied for third place in eight grade; Mark Sinclair and Jimmy Marchand, tied for first place in seventh grade; Bo Wood, second place in seventh grade; Dorien Llewellyn, third place in seventh grade; Kyle Hasak, first place in sixth grade; Olaf Corning, second place in sixth grade; and Dakota Wienges, third place in sixth grade.
Ideal Elementary School and Dream Middle School are privately owned schools located in Royal Palm Beach, offering preschool through eighth grade. The curriculum for both schools is based on Dr. Howard Gardner’s theory of Multiple Intelligence. For more information, visit www.idealelementary.com.
Happy parents, family members and friends were on hand Sunday, Nov. 23 to greet members of Seminole Ridge High School’s competitive band, the Winged Regiment directed by Tim Skinner, upon their return to the area. The returning students were escorted to the school from Seminole Ridge and Southern Blvd. by an escort of Palm Beach County Fire-Rescue and Palm Beach County Sheriff’s Office personnel. The Hawk band went to compete first at semifinals at Braden River High School in Bradenton. They won first place. Out of 21 bands, the top five bands went to St. Petersburg where they competed with other top-five bands in Class 2A. There were five different classes, and each class had five winning bands. The Hawks won first place in the finals for Class 2A. They won fifth place overall in the state out of 76 bands when the competition started.




The Urban League of Palm Beach County’s Center of Excellence is hosting a unique academic competition that tests area middle and high school teams in the areas of math and black history and culture. The Brain Bowl is a competitive academic contest based on an intensive study and understanding of black history and culture and math. Questions are derived from the Black Heritage Trivia Game as well as several historical books, including Wrapped in Rainbows: The Life of Zora Neale Hurston by Valerie Boyd and The Color of Water by James McBride. Nine teams from area middle schools, high schools and community-based programs
will compete for advancement to the state level competition on Sunday, Dec. 7 at 4 p.m. at the Kravis Center for the Performing Arts in West Palm Beach. The competition is designed to motivate middle and high school students to improve skills in writing, reading and math. Students prepare for the Brain

Bowl over a period of several months by reading college-level written works, learning and using advanced vocabulary in writing and speech, and exercising their writing, speaking and critical-thinking skills to compose and present essays on character-related principles. After training and preparation, students compete to test their knowledge and winners will advance to regional and then state level competition, which takes place in Tampa. The state champions will receive college scholarships and other prizes. The Center of Excellence is a community-based initiative whose goal is to identify and motivate disadvantaged minority elementary and secondary students to excel academically and culturally. The Urban League of Palm Beach County is celebrating its 35th year of service to the communities of Palm Beach County. For more information, contact Director of Development Kate Alvarado at (561) 385-4315 or kalvarado@ulpbc.org.













Binks Forest Elementary School teamed up with business partner the Barnes & Noble store in Wellington on Saturday, Nov. 22 for their fall bookstore fundraiser. With the help of Barnes & Noble Community Relations Manager Maryann Heidi and Binks Forest Media Specialist Sharon Wedgworth, members of the Binks Forest family were encouraged to come and celebrate their love of reading while portions of the profits were donated back to the Binks Forest schoolbook fund. The crowd was entertained by performances from the Binks Forest holiday chorus and the Orff xylophone ensemble led by Mrs. Karen LaFrance, and then treated to story time with Principal Dr. Julie Hopkins. Shown above, the Binks Forest holiday chorus performs for audience members.

Acreage Pines Elementary School held a flag-raising ceremony for the entire school on Nov. 11 in honor of Veterans Day. Members of Fire Station 21 and the Seminole Ridge High School marching band helped students commemorate the event. Fifth graders Julie Weber and Kaci Sleeth handled the flag-raising duties with the assistance of veteran John Hochella. Following the ceremony, Hochella told stories of his experiences in the Korean War. Pictured above, the SRHS marching band performs during the flag-raising ceremony.
Royal Palm Beach High School’s Medical Science Academy students recently participated in the program “Day in the Life of a Nurse” at Palms West Hospital.
Each year, the Nursing Consortium of South Florida, a coalition of hospitals, nursing schools, healthcare agencies and foundations, organizes the Day in the Life of a Nurse program for middle and high school students interested in pursuing a career as a registered nurse.
“This event provides high school students with an opportunity to shadow registered nurses and provide a glimpse into their future career,” said Silvia Stradi, president of the Nursing Consortium of South Florida and chief nursing officer at Palms West Hospital. “Our goal is to encourage students to continue pursuing their career in nursing and show them the life-
saving and sustaining tasks the nurses provide to patients.”
The students, accompanied by Academy Coordinator Karen Kissel, participated in the oneday program. The students toured the hospital, shadowed staff nurses, listened to various presentations and performed simple duties. All agreed that the highlight of the day was the landing of the Trauma Hawk. The students were mesmerized by the presentation and incredible capabilities of the emergency aero-medical program. Palm Beach County Fire-Rescue employees staffed each helicopter with one pilot, one registered nurse and one paramedic.
“The program is a great way for the students with a goal of working in healthcare to get an overview of what magic nurses perform everyday,” Palms West Hospital Education Director Michelle Leaf said.

The Palm Beach Central High School Bronco band made history at the Florida Marching Band Championships on Saturday, Nov. 22. In the band’s third trip to state, they finally broke through and made championship finals after an outstanding performance at the semifinals at which they finished third in Class 3A. The performance also yielded the Bron-
cos a Distinguished rating in Music.
The band performed in front of more than 15,000 people at the evening finals at the Tropicana Dome in St. Petersburg, home of the Tampa Bay Rays. The look on the students’ faces as they came onto the field in the dome was worth all the work they have put in since July. It was truly a moment the students

Panther Run Elementary School’s WPRE broadcasts every morning at the school. The news crew consists of fifth grade students. Each month, the news crew changes. Students had to audition for their positions. Shown here are: (front row, LR) audio engineer Julianne Dragunat, anchors Briana Mourad and Lindsay Besson; (back row) Principal P.J. D’Aoust, Director Stephen Owen, camera operator Gianna Duyos, teleprompter Erin Jones, Floor Director Yvan Laurent and ESOL teacher and Station Manager Patricia Figuero.



will remember for the rest of their lives. The Bronco band has now established itself as one of the elite marching bands in the state. It was the only band in its class to be a finalist for the first time. Now that the Broncos have broken the finals barrier, they can set their sights on bringing home a state championship. The band would like to thank all the supportive staff, faculty and administration for their support, as well as Strathmore Bagels for donating bagels for the band’s breakfast before competition. Palm Beach County also established itself as the premier county for marching bands. Seminole Ridge High School was the state champion in Class 2A, and the King’s Academy placed second in Class 1A.

Loxahatchee Groves Elementary School presented a Thanksgiving Program on the night of Nov. 18. The chorus performed a show of many thanks with a visit from “Bear” to sing about “the bear necessities of life.” The instrumental music ensemble performed on their drums, recorders and harmonicas. Both groups are under the direction of Mrs. Laurie Brisson. Shown above, the students perform with “Bear.”








Western Pines Middle School
Principal Robert Hatcher, along with staff and faculty members, are proud to present the students of the month for December. Selected by their math teachers, these students exemplify the best from Western Pines.
The student of the month in the sixth grade is Alanna Brescia. Alanna is a well-mannered young lady and a straight-A student in all of her subjects. In addition, she is always well-behaved and acts as a role model for other students. Overall, Alanna is an outstanding student who deserves to be recognized for her efforts and achievement.
The student of the month in the seventh grade is Steven Demeo. Steven is not only a stellar student, but he is also exceedingly kind to his teachers and classmates. Whenever anyone
On Friday, Nov. 14, more than 220 family members and friends of King’s Academy students enjoyed the school’s second annual shopping day at the Mall at Wellington Green. The day started with breakfast at WilliamsSonoma, shopping at the more than 40 participating retailers, followed by lunch/dinner at California Pizza Kitchen.
The event was a creative way for shoppers to take advantage of huge discounts at their favor-
needs anything, whether in the classroom or on the athletic field, Steven is the first to volunteer to help. He is a hard worker, and he always does what it takes to get the job done. The student of the month in the eighth grade is Jeremy Silas. Jeremy has always exhibited behavior most becoming to a Western Pines student. He works above and beyond with excellent results. What is most impressive about Jeremy is his moral fiber. Jeremy demonstrates the type of character that defines a great student and a great person. He is straightforward, responsible and reliable. In addition to Jeremy’s great academic efforts and outstanding character, he is also actively involved in Western Pines music programs, both instrumentally and vocally.
The Royal Palm Beach Village Council will award six $1,000 scholarships to high school seniors residing in the village. Seniors can pick up an application at their high school guidance office or at the Royal Palm Beach Village Clerk’s Office at Village Hall (1050 Royal Palm Beach Blvd.). The application can also be downloaded from the village’s web site at www.royalpalmbeach. com. On the left border, click on “scholarship information.”
The completed application must be postmarked no later than Feb. 17, 2009 or handdelivered to the Village Clerk’s Office by 5 p.m. on Feb. 17. Finalists must be available for interviews on March 21. The Education Advisory Board’s Scholarship Committee will make the final determination. Winners will be announced in April and the scholarships will be awarded at the council meeting on May 21. For more information, call (561) 790-5102.

ite stores and get a jump on their holiday shopping, while benefitting the students at the King’s Academy.
The school would like to offer a special thanks to parent Celia Moncholi for organizing the event and to TD Bank for generously underwriting the event and lunch.
More than $7,000 was raised to benefit TKA’s annual fund and the 2009 annual dinner and auction.



Western Pines Middle School teacher Deborah Burggraaf recently released her first book Caught in the Middle
The book, which is a collection of short stories, captures the essence of life in a sixth grade classroom. Burggraaf began collecting the stories while teaching in Oceanside, Calif., and she continued when she moved to Palm Beach County. Caught in the Middle offers parents and teachers valuable insight into the many challenges a teacher encounters dealing with middle school students as they transition from child to young adult.
Furthermore, parents and teachers will gain a deeper understanding of middle school students and how their personalities, home life and learning styles affect their success in the classroom. Burggraaf’s passion for teaching is clear. Her stories about the funny things middle school students do will amuse readers. Stories about students’ personal sacrifice and even abuse are gripping; stories of students overcoming shyness and a lack of self-esteem are equally inspiring. Also included in Burggraaf’s book are stories about
the people who have influenced her life. Her mother, her principal, fellow teachers and successful authors have all played a role in shaping the teacher that Burggraaf has become. Caught in the Middle is a must-read for parents who are curious about secondary learning at the middle-school level. Additionally, new teachers will gain strategies and guidelines for student success. Caught in the Middle is published by Protective Hands Communications in Riviera Beach. For more information, call (561) 841-4990.


Air Force Airman Jerod Eaton has graduated from basic military training at Lackland Air Force Base in San Antonio, Texas.
During the six weeks of training, Eaton studied the Air Force mission, organization, core values, and military customs and courtesies; performed drill and ceremony marches, and received physical training, rifle marksmanship, field training exercises, and special training in human relations.
In addition, airmen who complete basic training earn credits toward an associate in applied science degree relating through the Community College of the Air Force.
Eaton is the son of Russ and Dena Eaton of Wellington. He graduated from Palm Beach Central High School in 2008.

Zeid Iyad Shehadeh — son of Iyad and Karmeh Shehadeh of West Palm Beach was born at Palms West Hospital on Nov. 5.
Sofie Elizabeth Naranjo daughter of Freddy Naranjo Jr. and Marisa Ann Lang of West Palm Beach was born at Palms West Hospital on Nov. 6.
Yareli Lizbeth Ramirez daughter of Juan Ramirez and Mayra Garcia of West Palm Beach was born at Palms West Hospital on Nov. 7.
Shemiah Charnae Sanders — daughter of Tansanka Sanders of West Palm Beach was born at Palms West Hospital on Nov. 9.
Mikaela Cristina Martin — daughter of Michael and Karla Martin of Wellington was born at Palms West Hospital on Nov. 10.
Nina Montesano-Mills — daughter of Michael Mills and Julie Ann Montesano of Royal Palm Beach was born at Palms West Hospital on Nov. 11.
Jaylynn Marie Richards — daughter of John Richards and Jennifer Quinlan of Royal Palm
Beach was born at Palms West Hospital on Nov. 12. Christopher Mark Brady Jr. — son of Christopher Brady and Tirzah Rogers of Wellington was born at Palms West Hospital on Nov. 14. Morgan Sydney Simpson — daughter of Joseph and Savon Simpson of West Palm Beach was born at Palms West Hospital on Nov. 17.
Za’Kiyha Neriah Peoples — daughter of Onterion Peoples Sr. and Belinda Chavers of West Palm Beach was born at Palms West Hospital on Nov. 17.
Julianna Rose — daughter of Christopher and Jennifer Ayala of West Palm Beach was born at Palms West Hospital on Nov. 20. Jayden Anthony Stevens son of Calvin and Stacey Stevens of West Palm Beach was born at Palms West Hospital on Nov. 20.
Alona Manadyel Luckose — daughter of Biju and Manju Luckose of Lake Worth was born at Palms West Hospital on Nov. 24.
Thirteen-year-old Wellington resident Johnna Cesta is asking for the community’s help. For the past two years she has organized a stuffed animal drive for Christmas. She sent an e-mail to relatives and friends asking them to sponsor a stuffed animal by donating $6.50 to her as a Christmas present.
The $6.50 is enough to buy a stuffed animal (a bear, monkey or dog), a 20’ x 20’ mini-blanket that Cesta cuts out of fleece, ribbon to tie around the necks of the stuffed animal, and a candy cane.
With help from her family, Cesta assembles the stuffed animals by tying a ribbon around their necks and attaching the mini-blanket and the candy cane to them with a rubber band. Cesta then donates her creations to a variety of places such as a children’s oncology clinic and various soup kitchens. In her first year, Cesta gave away 81 stuffed animals, and last year she offered more than 130.
Cesta has organized another drive for this year. However, in
light of the difficult economy, Cesta has partnered with the Starbucks at the corner of Forest Hill Blvd. and Wellington Trace to raise money for the Church of the Holy Redeemer’s feeding program in Lake Worth and collect blankets for them to hand out.
“They are a great charity organization that needs help,” Cesta said. “They coordinate daily meals Monday through Friday, over 2,600 meals a month, and have a food pantry on Tuesday that provides food, clothing and other items when available to care for the homeless and needy in our area.”
Cesta will be at Starbucks on Saturday, Dec. 6 from 9 a.m. to 1 p.m. to accept donations. She noted that Starbucks Manager Shawn McCarthy has offered to give a free drink to anyone who donates a blanket or makes a contribution to the Church of the Holy Redeemer.
Starbucks is located at 12840 W. Forest Hill Blvd. in the Wellington Plaza. For more information, call (561) 3332049.

Palms West Presbyterian Church in Loxahatchee Groves held its annual Bountiful Harvest on Sunday, Nov. 23. The day featured a worship service at 10 a.m., followed by a picnic fellowship lunch. Shown left, members of the congregation prepare for the service and later enjoy the picnic lunch.
Army Pvt. Jonathan Harker has graduated from basic combat training at Fort Sill in Lawton, Okla. and Army Pvt. Luis Marti III has graduated from basic combat training at Fort Jackson in Columbia, S.C.
During the nine weeks of training, they studied the Army mission, history, tradition and core values, physical fitness, and received instruction and practice in basic combat skills, military weapons, chemical warfare and bayonet training, drill and ceremony, marching, rifle marks-




manship, armed and unarmed combat, map reading, field tactics, military courtesy, the military justice system, basic first aid, foot marches, and field training exercises.
Harker is the grandson of Annette Schmidt of Quincy, Fla. and Susan Flanagan of Wellington.
Marti is the son of Vivian Marti of Royal Palm Beach and grandson of Lillian Lanza of West Palm Beach. He is a 2003 graduate of Royal Palm Beach High School.




The Wellington Art Society presented its fine art and fine craft outdoor festival Fall Fling 2008 on Saturday and Sunday, Nov. 22-23 at the east field of the Wellington Community Center. The event included the 2008 Youth Art Exhibition. The winners are as follows:
• Elementary Level — First place, Angela Liu, Tea Party watercolor; second place, Michael Wang, Red Cats, watercolor; third place, Luke Han, Horse in the Country, watercolor; and honorable mention, Michael Wang, Friendship, watercolor.
• Middle School Level
First place, Elizabeth Williams, Awakenings , acrylic; second place, Wendy Huang, Patience, acrylic; third place, Wendy Huang, Venice, watercolor; and honorable mention, Nina Mangiola, Liberty, clay.
• High School Level — First place, Andrea Erickson, Lack of Spur, clay; second place, Andrea Erickson, Contentment¸ pastel; third place, Megan Byrne, Serenity, digital photography; and honorable mention, Andrew Phillips, Brothers, acrylic. For more information about the Wellington Art Society, visit www.wellingtonartsociety. org.




Royal Palm Beach High School honored veterans on Veterans’ Day Tuesday, Nov. 11 at the school’s flag pole. Dance Director Michele Blecher organized the ceremony. During her welcoming remarks, Blecher held pictures of her eldest son Matthew, who is deployed in Iraq with the 1st Armored Division/3rd Brigade Combat Team/4th Infantry Division Multinational Division, Baghdad. Principal Guarn Sims made opening remarks, and the chorus sang a beautiful rendition of the “Star Spangled Banner” followed by the presentation of a wreath by Bernadette Fitzpatrick escorted by National Guardsman Jarrod Sotolongo. The ceremony continued with the band playing “Mutual March.” The Wildcat dance team danced to “You’re a Grand Old Flag,” the chorus sang “Let There Be Peace on Earth” and the Wildcat dancers danced another routine to “American Soldier.” (Above) the Royal Palm Beach High School dancers. (Below) The Royal Palm Beach High School chorus.

Eleven-year-old Alex Ng of Royal Palm Beach has been doing charity work since he was seven.
Each year he does odd jobs around his neighborhood to earn money to buy toys for children in Belle Glade. Ng donates 100 toys annually.
This year, his soccer team, the Royal Palm Beach Strikers, placed first in the 11-and-under recreational league division. Ng won the Outstanding Goalie award.
In addition, Ng’s friend Andre Ferrera was the soccer shoot-out first-place winner. These two youngsters both hold an A average in school, excel in soccer, and now they are doing charity work together. During a time of year when kids are thinking about Xboxes, Wiis and other gifts they want for the holidays, Ng and Ferrera are thinking about how they want other kids to be able to enjoy the season.
• • • Send Palms West People items to: The Town-Crier, 12794 W. Forest Hill Blvd., Suite 31, Wellington, FL 33414. Fax: (561) 793-6090. E-mail: news@goTownCrier.com

Andre

Ferrera and Ng show off the trophies from their soccer championship.




By Candace Marchsteiner Town-Crier Staff Report
Author’s note: In June, while covering a story about a Florida Trail Association hike through Okeeheelee Park, several members spoke with anticipation about the annual trail hike around Lake Okeechobee.
I’d made a “things I want to do in Florida” list several years ago, and I was excited to hear that not only was it possible, but that a group of people have done it every year for the past 16 years! I ordered the official guide and marked my calendar for the Nov. 22-30 adventure. In the guide were photos of adults, many well into retirement. If they could do it, a somewhat fit, tailend Baby Boomer could do it, right?
Frigid temperatures and biting wind gusts did not deter more than 110 walkers from starting the Florida Trail Association’s 17th annual hike around Lake Okeechobee on Saturday, Nov. 22. The nine-day, 109-mile, counterclockwise adventure was sponsored by the association’s Loxahatchee chapter and attracted hikers from across Florida as well as Colorado and Washington.
The complete hike was optional, and many chose to join the group for one to several days. While some stayed at local hotels, most of the group camped at reserved spots at Okeechobee KOA for the first four nights and the South Bay RV Park for the last four nights. Each day began at twilight so hikers could witness the sunrise and cover most of the day’s route during cooler morning hours.
At late afternoon happy hours, hikers gathered at picnic tables to socialize over snacks and drinks and decide which restaurants would get their early bird dinner business. Each night, during a mandatory 7 p.m. meeting for the next day’s hikers, the group talked about the day’s extraordinary events and sightings and what to watch for on the next leg.
This year’s wagon master and trail angel Mike Levitt, who goes by his stage name Mike Nomad and is the FTA’s trail section leader for the DuPuis area, waited at designated rest stops in case a hiker could not finish or needed assistance. Certified as a first-responder, Mike also acted as liaison for the campgrounds and a travel guide for area restaurants and sights. Although Mike, a part-time actor, property manager and chainsaw team worker, completed the hike twice in previous years, he finds himself drawn back to the event because of the surrounding communities. “I like the variety of mom-and-pop restaurants, hometown activities, fishing, camping and the people,” Mike said.
Paul Cummings, FTA trail section leader for Lake Okeechobee, served as the sweeper, following the last hiker to ensure that everyone was accounted for. Cummings and fellow hiker Gordon Johnson of West Palm Beach are the only hikers to have completed the hike every year. Cummings, a retired U.S. Air Force major, explained how the tradition began. “We started the hike for three reasons,” he said. “One, we wanted to encourage people to walk, get exercise. Two, in our first year we had just established the trail along the lake. And three, we wanted to bring some money out into the surrounding communities. We want to help boost their economy.” Cummings added that the event generates between $15,000 and $20,000 for lakeside communities through camping fees, dining out, shopping and gas purchases. The hikers themselves were a diverse group there for diverse reasons: a lawyer on sabbatical, a firefighter making family time with his two sons, a teacher keeping loneliness at bay after losing a parent this year, and a
web site manager adding to his list of accomplishments while working at Internet cafés and public libraries along the way, just to name a few. All were among the characters in this nine-day adventure. Lake Okeechobee is surrounded by the Herbert Hoover Dike, an earthwork levee built to protect the area from the sort of massive flooding that caused substantial loss of life in the wake of the 1928 hurricane. The Florida Trail Association’s marked trail, also known as the Lake Okeechobee Scenic Trail or LOST, runs atop the dike with occasional routes along the roadside.
The first day of the hike kicked off at the late hour of 8:04 a.m. and included a “wimp walk,” a three-mile journey from Pahokee north to Canal Point. FTA volunteers greeted walkers with continental breakfast selections and morning beverages at numerous rest stops on the first day. The Palm Beach County Sheriff’s Office Eagle Academy generously shuttled walkers, including a Girl Scout troop, back to the starting point. The lake’s choppy surf provided a backdrop for bird sightings, including turkey vultures, ibises, egrets, herons and an eightfoot alligator soaking up sun. Just after noon, most hikers had finished the 11.9-mile hike in Port Mayaca.
The second day saw hikers on the path by 6:30 a.m. This leg became the “Trail of Carnage,” with unexplained blood trails coloring the paved path. Hikers heard gunfire from nearby hunting camps and came across a dead wild pig. An area of white feathers suggested an ibis fell afoul of a predator. The 13.7mile leg from Port Mayaca to Henry Creek offered the agony of “de feet” as some hikers nursed blisters and enjoyed afternoon naps.
Hikers welcomed the third day, a short 9.3-mile jaunt from Henry Creek to Parrott Avenue Wayside Park. Warmer temperatures brought sightings of diving pelicans, woolly caterpillars and velvet ants, and a lucky few spotted otters and manatees in the dike’s rim canal.
The fourth day felt like a road to nowhere involving 14.7 miles from Wayside Park to Indian Prairie through the lake’s western farmlands, where grazing cattle and galloping horses dotted the fields. Fearless sandhill cranes hunted casually along the initial paved stretch of trail, often crossing paths with hikers. Along the lake’s marshy coastline, dead melaleuca trees stood like tall silhouettes. The longer journey found hikers baking in the hot noonday sun with no shade in sight, and the rutty, longer stone-filled path appeared endless as the heat created an oasis-like haze in the distance. One hiker caught a glimpse of an alligator launching after a trio of egrets without success.
The fifth day’s 12.5-mile leg from Indian Prairie to Lakeport gave walkers a glimpse of the “hikers’ graveyard,” a scattering of implanted marble stones serving as reinforcement. After the hike, campers moved to South Bay RV Resort for the remainder of the trip.
The sixth day brought Thanksgiving Day relief — only 9.4 miles from Lakeport to Moore Haven past a new garbage dump and several construction sites. In the late afternoon, campers and visitors met at the historic Clewiston Inn for a holiday buffet followed by the traditional, homespun “(no) talent” show. Entertainment included a bluesy hiker’s song, a tai chi demonstration, joke telling, travel poetry recitations and story excerpts. Hikers burned off the calories on the seventh day with an 11.9mile leg from Moore Haven to Clewiston. Many took advantage of a halfway stop at Uncle Joe’s Fish Camp for coffee and snacks. This leg offered the best photo opportunities of gray fox in the event’s history, and sev-

eral hikers witnessed circular rainbows as the sun’s rays bounced off the morning mist. The eighth day featured the event’s second-longest hike, 13.8 miles from Clewiston to South Bay. Heading east, the hillside along U.S. 27 appeared covered with a light frost because the sunlight twinkled on an abundance of dew-covered cobwebs. This leg also offered the strongest reminder of civilization as holiday travelers and truckers whizzed by, obligingly honking their horns and likely unaware of the expanse of beauty on the lake beyond the dike.
The final, ninth day took hikers 11.8 miles from South Bay to Pahokee. Ironically, the last official day of hurricane season brought jarring wind gusts. Apparent morning downpours in Pahokee turned out to be windblown dust clouds and fire ash from neighboring fields. Other than vultures surfing the air currents, few animals were visible. Hikers marveled at their good fortune with weather up to this point, as the first rainfall hit while everyone packed up their campsites and said their goodbyes.
Author’s endnote: Looks are truly deceiving. Of the 109 miles, I walked or hobbled 84.6 of them but intend to make up the rest. My 12-year-old daughter Summer managed 72.7 miles. After Day 1, I said that my goal was to cross this off my list and be done with it. By Day 8, even with painful feet, I’d do it again. We’re fortunate to live so close to the country’s secondlargest freshwater lake and especially one with a marked trail. While the land is flat, it does vary and offers an open view of critters and an incredible skyscape. For more information about the Hoover Dike, visit the U.S. Army Corps of Engineers’ web site at www.saj.usace. army.mil. For more information about the Florida Trail Association and their ongoing events, visit www.floridatrail.org.







On Monday, Dec. 8 at 1 p.m., Palms West Hospital will hold a recognition ceremony for members of the Wellington Art Society to thank them for their generous donation of artwork to the hospital. Wellington Art Society members donated close to 50 pieces of artwork for Palms West Hospital’s Pediatric Department and Pediatric Emergency Room. The purpose of the artwork is to cheer kids up and comfort them while in an uncomfortable
continued from page 1 adding that he pays $1,000 a month to have his daughter’s horse kept in a commercial stable.
Langsam asked why Paddock Park 1 was excluded from eligibility for stables, and Hodgkins said it had been excluded from the equestrian overlay because the lots were generally smaller, whereas lots in the EPA are typically more than two acres.
Resident Frederick Jorn said he agreed with the concept of restricting the number and sta-
hospital environment. “Thanks to the generosity of local artists who are members of the Wellington Art Society, our young patients and their families will be in better spirits with the colorful and uplifting artwork surrounding them,” Palms West Hospital CEO Bland Eng said.
On Aug. 26, Wellington Art Society member artists gathered for a special “Paint Day” to create the custom works for the exhibit, which is the first in a series of arts-related service
bling of horses on lots smaller than two acres. He wondered how many people at the meeting live next to a one-acre lot with horses.
“I am the equestrian representative [on the board],” DiFonte replied. “I have horses. I love the smell of horses. You don’t want to go there.” Jorn said he knows of one Paddock Park resident who had stopped keeping horses about a year ago, and the property is more attractive now.
PZA Board Chair Steve Delai recommended sending the draft ordinance back to village staff for consideration of the points raised. “There are a number of questions that need to be answered,” he said. “Just because you live on a bridle trail
projects under the society’s new Community “ArtReach” Program, designed to enrich the lives of those in need through the use of the visual arts. The program is made possible through donations and sponsorships.
Founded in 1981, the Wellington Art Society is open to artists of all mediums and patrons of the arts, providing both local and regional artists the platform to share their work, learn more about their craft and
does not give you the right to have horses.” Delai said he would prefer to see an ordinance that doesn’t discriminate between those who do and do not live on a bridle path. “We need to flesh this out a little more,” he said. “There are some equity issues we need to look at.”
Board Member Alan Medoff said he is very concerned about the septic tank and well question. “I was on the board in 2001, and the reason it was removed was it was not developing as an equestrian area, but the single most important issue is whether they are on septic or city water,” he said. DiFonte felt the comments presented were all well thoughtout. Although he favors expand-
serve the community through their art. A charitable organization, the society’s mission is to educate and encourage originality and productivity among its members and area youth through programs designed to further the advancement of cultural endeavors in the western communities. For more information on the Wellington Art Society’s ArtReach Program, contact Karen Knight at (561) 798-3240 or artforum9@aol.com.
ing the number of residences allowed to build stables, he said another concern is access to the one-acre lots to stock feed and clean out manure.
“I don’t know how you would access it,” DiFonte said. “You would have to drive through the front yard. Those are very large trucks that can create all kinds of problems for you. I agree with the Equestrian Committee, which recommended expansion of the equestrian area. I’ve had horses since I was three years old. I can see where the young lady here can learn a lot of life lessons from horses. You treat them well, they treat you well, but we need to address some of the environmental concerns.”
Pine Jog Environmental Education Center’s Go Green for the Holidays & Music in the Forest
Saturday, December 6 and 13 10 am – 4 pm
Discover how to make your holidays more green, take a stroll on the trails while listening to music and enjoy fun crafts and activities for the kids!
561-686-6600
6301 Summit Blvd. • West Palm Beach, FL 33415 www.pinejog.fau.edu






















































895 1,183 1,471 1,760 2,048 2,337 2,625 2,913 3,202 3,490 3,778 4,067 4,355 4,643 4,932 5,220 5,508
Thousands turned out for the inaugural Palm Beach Steeplechase held last Saturday at the Palm Beach International Equestrian Center Stadium in Wellington. The event offered a mix of exciting horseracing over fences, gourmet food, wine tasting, boutique shopping and tailgating along the rail of the newly created course. For more info., visit www.palmbeach steeplechase.com. PHOTOS BY DENISE FLEISCHMAN/TOWN-CRIER













The Phantoms Visit
11365 Legacy Avenue, Palm Beach Gardens (561) 630-4994
See what fine service is all about: old school, professional and attentive.
Even with 94 restaurants now on the PGA Blvd. “restaurant row” in Palm Beach Gardens, the national reputation of the Capital Grille steak house has had crowds beating down the doors of its Legacy Place location from day one! Excellent food, service and ambiance lead to success, and that is what sets the Capital Grille apart from the competition.
This without a doubt is “the place to see and be seen” for a power lunch, lively happy hour or latenight cocktails, or treating yourself to one of the best steak dinners anywhere. With 35 locations across the country, the Capital Grille is worth a special trip, and over the years, whenever we visited Fort Lauderdale, Miami, Orlando or Naples, we made special effort to dine at the local Capital Grille. Now it is in walking distance of our home.
The dry-aged steaks are huge and flavorful, the wine list extensive, the service is impeccable, and the décor is rich dark wood, with deep burgundy walls, Persian rugs and elegant works of art, all enhanced with soft lighting to create an atmosphere of a gentlemen’s hunt club, an exclusive yacht club or the library dining room of an art museum. Everything is upscale: the linens, cutlery, stemware and china all are part of your dining experience.
Perhaps the combination of fine wines and great steaks has never been more apparent than at the Capital Grille. The wine list is an award winner with hundreds of wines, from the best wine regions worldwide, priced from $30 up to $1,025 for the Chateau Lafite-Rothschild 1989.
Appetizer selections ($13 to $47) include Kobe beef carpaccio, prosciutto-wrapped mozzarella, smoked salmon, oysters on the half shell, caviar, pan-fried calamari and the cold shellfish platter.
Soups and salads ($7 to $13) include clam chowder and French onion soup ($8) topped with moz-
zarella & Jarlsberg cheese, which tops our list of comeback items. Other equally impressive items are Caesar salad, the wedge with bleu cheese and crumbled bacon, mozzarella and tomato with basil, and the famous Capital Grille Chopped Salad.
Main courses ($24 to $45-mp): filet mignon, dry-aged steak au poivre with Courvoisier cream, filet oscar, porterhouse, sirloin, Delmonico and tenderloin, all aged, cooked to order and served with any topping. Again, their steaks are the backbone of this high-end chain’s success. Veal, lamb and pork chops along with a variety of seafood selections, including grilled swordfish, sesame tuna, glazed salmon and broiled lobsters, are also available nightly.
Side dishes ($8 to $12): the lobster mac ’n’ cheese ($12), like the French onion soup, is five-star. Other favorites are mashed, lyonnaise and au gratin potatoes, Vidalia onion rings, creamed spinach, parmesan truffle fries and seasonal veggies.
Desserts ($6 to $9): all desserts are prepared daily and all 11 are definitely not calorie conscious… In fact, we are afraid you may gain weight if we list them all, so here are a few of our favorites: coconut cream pie, flourless chocolate espresso cake, double chocolate hazelnut cake and classic crème brûlée.
Now you can follow the crowds to the Capital Grille for cocktails in the lounge, lunch Monday-Friday 11:30 a.m. to 3 p.m., or dinner Monday through Thursday 5 to 10 p.m., Fridays and Saturdays 5 to 11 p.m., and Sundays 4 to 9 p.m. Reservations are highly recommended (there is no recession here). Call (561) 630-4994 and please tell them that Joe and Kathryn, the Phantoms, highly recommended you call. For more information, visit www.the capital grille.com.
Joe & Kathryn, the Phantoms, are featured writers for the TownCrier newspaper and www.your news.com. Comments are welcome at thephantomdiners@aol.com.
Children’s librarian Cindi Permenter taught 19 children the art of candle-making Tuesday afternoon, during one of the Wellington library’s many after-school programs. Crafters learned how to color candle wax with crayons, set wicks and create molds. Information on library programs can be found in the monthly “Happenings” brochure available at branch locations or online at www.pbclibrary.org.


If you prefer a puppet show to a sermon, if casual dress and wiggling is more your style of worship, or if your family has youngsters aged eight and under, then Temple Beth Zion’s Young Family Shabbat Service is for you. This child-friendly, family-orient-


At Temple Beth Zion In Royal Palm Beach ed, Friday night service takes place monthly. The temple’s next Young Family Shabbat Service will take place on Friday, Dec.12 from 6:30 to 7:15 p.m. This month, instead of a sermon, Rabbi Bertram Kieffer will delight the congregation with the puppet show “Judah, Who Always
Said No!” The temple invites the community to join in the fun. Temple Beth Zion is located at 129 Sparrow Drive in Royal Palm Beach, just north of Veterans Park. For more information, call Dianne at (561) 7988888 or visit the temple’s web site at www.templebethzion.net.















I’m into my second week of holiday gift-buying because — amazingly — I still have a little money left. I’ve taken care of all the kids (ages one to 30) at the toy store and now I’m on to the adults (“kids” ages 31 and up). For them, I always start at the bookstore because bookstores have something for everyone. It’s not the same “something” but somewhere among the stacks is “the perfect gift” for each and every intended recipient.
Bookstores aren’t like they used to be. They’re still magical places that smell great and cast a spell over me, but there are a lot of new categories for things like “the language of pets” and “psychic health.” There are calendars, reference books and magazines. There are books with attachments — craft kits, bookmarks, calligraphy pens and so on. In addition, many bookstores offer stationery, CDs

and muffins. (Cautionary note: muffins are usually not the perfect gift, particularly if they have to be mailed.)
For my dad, I look for a series of paperback adventure stories or westerns, but for mom, nothing but the latest official Scrabble dictionary will do. The Scrabble dictionary started, of course, as a Scrabble altercation when she plopped her Y
tile down at the end of my word cheddar. The Y also sat on a triple word score, so no less than 54 points were at stake!
“Cheddary is not a word!” I shouted.
“‘That bread has a nice cheddary flavor,’” she quoted smugly.
“What bread?” (Dad’s hearing is good but he’s not always focused, particularly once food is mentioned.) “When did you bake bread?”
“There’s no bread, Emmett.”
“Mom, I just cannot allow cheddary.”
“Look it up!” she yelled. “Challenge your own mother!”
I got up to find the dictionary.
“Did Debbie make the bread?” dad continued.
“We’re talking about cheddary.”
Cheddar cheese bread? Where is it?”
“The word, not the bread, dad! Mom, so sorry
but the Official Scrabble Players Dictionary does not list ‘cheddary.’”
“I don’t believe it. Let me see that.”
To make a long story short, her 1991 Scrabble dictionary did not include cheddary but neither did it list the word fax, still believing it to be an abbreviation of sorts for facsimile. Immediately following my win, however, Mom shuttled me into the car and headed for the nearest bookstore. She yanked me straight over to the games and puzzles section and commanded, “now look it up.” Of course it was in there, and of course I had to buy her the book. So that’s how that tradition got started.
As for dad, we brought him a loaf of cheddary bread to keep the peace, but I don’t do that every year. Still, I wonder how he’d feel about a muffin?
Twilight is a strange kind of vampire movie. The basic notion of vampirism, blood exchange leading to domination, is essentially a Victorian take on unfulfilled longings. Bram Stoker’s Dracula, by far the best known of this type of fiction, has come down to us in a long series of movies that often reflect our own times more than originally intended. Dracula is sometimes an ugly monster, sometimes a suave lover, sometimes in a wide variety of guises.
In Victorian times, women were not supposed to be willing sexual partners. But Count Dracula and the others of his kind could mesmerize their partners through blood (symbolizing other bodily fluids that could not be mentioned). The two women in the original book, Lucy and Mina, could not be held accountable for their feelings and actions because of the hypnotic control of the vampire.
By Leonard Wechsler

century literature? The two men (as opposed to the vampire) are lonely, isolated figures who might find redemption through the love of a good woman. In the novels, as opposed to the movie versions, Darcy succeeds and Heathcliff fails. But women are attracted to the Byronic hero, lonely and with as many dark traits as good ones.
Women tend to admire men like these. Talk about fixer-uppers! In Twilight, young girls are a large part of the audience. And only a young girl could enjoy watching the central character Bella (Kristen Stewart) go among the vampires, casually telling Edward’s family that if things don’t work out she understands she could be their dinner. Not to mention her desire to become a vampire as well.
and old-fashioned. The kids all are sweet and looking for true love. Bella and Edward can only share long glances and hugs since he is terrified that if he has sex with her, he might kill her. The film, adapted from a series by Stephanie Meyer, reaches its best (and only exciting) moments near the end when the bad guy chases Bella. Aside from that, it could have come from the 1950s. “Gidget Meets Dracula” — what a concept!
Twilight is a modern version in which the vampire does not want to prey on people. And why not? The young Edward Cullen (Robert Pattinson) jokingly calls his family “vegetarians” because they only prey on animals other than humans. Although his classmates are not aware of his age, he has been 17 since 1918. The young heroine of the film is properly sympathetic to his plight of having been through high school dozens of times. A fate worse than undeath!
I have generally felt that the vampire is a particularly attractive figure for women. How different after all is the suave count (to my mind best seen in Frank Langella’s 1979 portrayal) from Darcy and Heathcliff, the romantic figures in 19th
The movie seems designed for prepubescent romanticism. There’s a bit of brief kissing, a few hugs, and not much more in the way of sexuality except from bad guy vampire James (Cam Gigandet) who describes Bella as a “snack” and really means it. Love is everything in this film, pure
The acting, particularly by the leads, is pretty good. The scenery at times is spectacular. Unfortunately, the “well, we can’t do much but look at each other and long for each other” love works best for the really young. Bella is bright and feisty, even if more than a bit suicidal. And Edward, at least, knows his limits. Bella might end her own life loving Edward, but in the immortal words of Joe E. Brown in Some Like It Hot when he discovers his new love Jack Lemmon is really a man: “well, nobody’s perfect.” And neither is this film.
A couple of weeks ago the CEOs of the “Big Three” United States automakers appeared before Congress with their tin cups. The only thing missing from this show — which went into reruns this week — was the monkey and the organ grinder. Of course, it didn’t help the CEOs that each arrived in Washington aboard a big private jet. Do they think we are all that dumb? (I guess so.) They went to Washington asking for a $25 billion bailout, flying in on their corporate jets.
The congressmen asking the questions to the three CEOs appeared to be throwing softballs instead of hardballs, of course.
By Ernie Zimmerman

get out of its deal with Tiger Woods is a step in the right direction, but that is only the tip of the iceberg in Saving Money 101.
One of the first things the Big Three need to do is cut out most if not all of their national advertising. It seems like every other ad on TV is a car ad. These ads cost millions. Most Americans are very loyal to one car brand or another. They don’t need to be bombarded with their ads.
do not have the union problems the Big Three have.
In the last three months, the U.S. Treasury has given out billions of dollars to banks, insurance companies and stock houses, among others. I think now is the perfect time to invest money in companies that make ink used for printing greenbacks, because the federal government is printing a lot of money. Then again, the government doesn’t have much “in the bank” to back the money they are printing. But it’s business as usual in Washington, D.C. I do not hear one person in Congress asking where all of this money is coming from.
Usually when you give money to somebody, you are taking the money away from somebody else. That is, unless you keep printing useless paper that looks like money. Didn’t Washington hear that the country is trying to go green? I guess not. I do have some ideas how the Big Three automakers can save some money. GM’s decision to



Almost everyone in the western communities reads the Town-Crier. Most folks outside the western communities think we are an upscale area. I think the Big Three will get more bang for their buck by placing ads in the Town-Crier and similar papers around the country. They will save millions of dollars by using this kind of advertising logic.
Another thing they need to do is renegotiate their union contracts. The unions are a major part of the problem for the automakers. The Japanese car companies that have factories in this country
I think the unions are smart enough to realize it is time to sit down with the Big Three and redo all the union contracts. I don’t think the auto unions would like to see one or maybe two of the Big Three close up shop. It would put thousands of their members out of work. Now don’t get me wrong; I am not anti-union. In fact, I still am a dues-paying member of a union. I just think common sense is needed at this time. All the money the Big Three would save by cutting national ads and the cost savings on new union contracts would allow them to lower the price of all their car models. I see at least $10,000 in price reductions on a lot of their models. If these things happen, the CEOs would no longer have to go to Washington with their tin cups. They would be able to see their cars leaving the dealers’ lots in record numbers. I can dream, can’t I?


























By Paul Gaba Town-Crier Staff Report
It was a botched handoff between Vero Beach High School quarterback Shawn O’Dare and running back Ben Harrison, less than two minutes into the Class 6A regional semifinal game last Friday night against Royal Palm Beach High School. RPBHS defensive end Perry McIntyre’s eyes lit up. He pounced on the ball, cradled it in his hands like a present on Christmas morning, and scampered untouched 30 yards into the end zone.
Just like that, on a crisp, chill Friday night, 1:57 into the contest, the Wildcats had taken control of their matchup with the Fighting Indians. For the next 46 minutes, the Royal Palm Beach faithful who braved the cold and drove more than an hour north saw the boys in teal, silver and black put on a clinic in defensive tenacity and big offensive plays.
Royal Palm Beach jumped in front early, dominated late and controlled the action between the bookend plays. The result: a 28-13 Wildcats victory at Vero Beach’s Citrus Bowl, setting up a home contest this Friday against defending 6A state runner-up Orlando Boone High School. While the Wildcats held a two-score advantage for most of the fourth quarter, Vero Beach threatened several times down the stretch. Victory was not truly in sight for Royal Palm Beach until back-to-back sacks of O’Dare — the second at the hands of McIntyre with 2:45 remaining on the clock. Only then did first-year RPBHS coach Darren Studstill’s troops begin to celebrate.
Royal Palm Beach (11-1) won its tenth consecutive contest after a season-opening 13-7 defeat to Dwyer. Studstill said the defensive pressure was key in his Wildcats’ taking it to the home team. “We wanted to start the
game with our defense, and we were fortunate to get a big play from them,” Studstill said. “We live and die with that defense.”
The fumbled handoff was the first offensive play for Vero Beach (9-3) after holding Royal Palm Beach to a three-and-out opening possession. But if anyone thought the host Fighting Indians would pack up and go away, they were mistaken. Vero Beach turned a Wildcats fumble into three points of their own less than one minute into the second quarter, on a 19-yard field goal by Patrick Baker, cutting its deficit to 7-3.
Royal Palm Beach responded quickly. On its first play from scrimmage after the field goal, Wildcats quarterback Marvin Payne hooked up with receiver Chris Dunkley on a 71-yard strike down the left sideline. With 10:47 remaining in the half, Royal Palm Beach had a 14-3 lead. “We saw that he [Vero Beach safety Zeke Motta] was very active, and we wanted to stretch the field,” Studstill said. “Marvin made a great pass, and Dunkley made the play.”
After Baker connected on a 42-yard field goal to trim the Wildcats’ lead again, Royal Palm Beach dug deep and used a bit of trickery to strike again. First, facing a fourth-and-two at the Vero Beach 33 yard line, Studstill opted to try for the first down. Payne handed off the ball to Derrick Sneed — normally a defensive linesman — who rumbled three yards and allowed the Wildcats to retain possession. It appeared the unconventional move would backfire when a few plays later Payne was sacked for a 15yard loss. But Payne hooked up with wideout Eric Peterson on a 34-yard touchdown pass with 3:47 left in the second quarter that helped to give the Wildcats a 21-6 lead. Payne complet-


ed 10 of his 17 passes for 203 yards and a pair of touchdowns.
Vero Beach appeared to regain momentum on its ensuing possession, driving 81 yards in 150 seconds, capped by a 13-yard pass from O’Dare to Stevie Wallace on a fourth-and-goal play with 1:06 left in the half, making it 21-13 at the half. The score was set up by a 50-yard aerial connection from O’Dare to receiver Clayton Hall.
The second half was void of scoring until 10:16 remained in the fourth quarter, when senior John Giles — making his first start at running back — galloped 60 yards for what turned out to be the game’s final score. The touchdown was set up by Jordan Dangerfield’s 25-yard interception return, which had taken place at the Wildcats’ one yard line, thwarting an 87-yard Fighting Indians drive. That Vero Beach possession had begun at its own two yard line after Giles had been stuffed by the Fighting Indians’ defensive line on a fourth-and-goal from the two yard line midway through the third quarter.
“John Giles has been itching to play all season, and he made the most of his opportunity tonight,” Studstill said. “He had a great week of practice, and he really stepped up.”
Giles gained 86 yards on 12 carries.
Vero Beach had several possessions after Giles’ score, but was unable to cross the goal line. On their first such possession, the Fighting Indians managed to drive to the Wildcats’ 33 yard line, but were stopped on a fourth-andsix.
The host Fighting Indians got the ball back with 2:45 left, after Royal Palm Beach failed to convert a fake punt on a fourth down of its own. But the Wildcats swarmed all over Vero Beach, capping their stellar performance with the back-to-back quarterback sacks.






Did you know that there’s no such thing as a white horse?
Horses come in a broad range of colors, but white isn’t one of them. Most of the time, when people see a white horse, it’s actually a gray. Gray horses typically, though not always, are born with black or dark brown coats. They gradually lighten with age, going through stages of dark (steel) gray to light gray to white, sometimes with dapples, but their skin remains black. Albinos have pink skin and may also have blue eyes, but albino isn’t a color — it’s a lack of color.
According to the book Horse Color Explained by Jeanette Gower, horses have only two different colors in their coats: black and red. All the possible color combinations result from their presence or absence!
The most common horse color is chestnut or sorrel, a reddish brown. They can have brown or flaxen (lighter) manes and tails, and the base color can vary from light to very red to dark, or liver chestnut.
Bays are the next most common color. These have brown coats, from bright (lighter) through blood (darker red). Bays have black manes and tails, as well as black on the lower legs. They may also have black ear tips. Brown horses, a separate and less common color, have no black on them. Black horses are all black and are relatively rare. True black horses have no lighter areas fading to black, say around the muzzle or eyes. As with “white” horses, many people seeing a dark bay may mistake it for black. Any horse can also have certain common white markings, typically on the face or lower legs, reA Horse Of A
By Ellen Rosenberg

ferred to as “chrome.” White on the face can be a star, a spot between the eyes, a stripe running all or part of the way down the face or a snip, a spot between the nostrils. If a horse has all three, many people refer to them collectively as a blaze. A bald face means some of the white spills over onto the sides of the horse’s head. Bald faces also sometimes affect eye color, and this horse may have a blue or partially blue eye if there’s a lot of white on that side.
White on the legs is usually limited to below the knees. They can be pasterns, just the lowest part; socks, halfway between the hooves and the knees; or stockings, which come almost up to the knees.
Many breeds of horses, such as Thoroughbreds and Arabians, can be any of the above colors. Some registries, like the Jockey Club, bar certain colors or patterns, and limit the amount of white on faces and legs. Other registries, like the American Paint Horse Association, are all about color.
Solid-color breeds include buckskins and duns, whose coats vary from dark or light tan to mouse. They may have black manes, tails, ear tips and sometimes legs. Duns also commonly have a dark-
er dorsal stripe running down the center of their backs from withers to tail, and sometimes “zebra stripes” on the lower legs.
One of the most common solid-color breeds is the Palomino, instantly recognized for its golden coat and dazzling white mane and tail. It’s hard to look bad on a flashy Palomino. Where would Roy Rogers have been without Trigger? Cremellos are similar to Palominos but much lighter in color. They may also have blue eyes.
Roans are horses with a basic solid-color coat but a lot of individual white hairs overlaying the base color. Some horses may have roan patches, and some are roan all over, looking lightly speckled. As with grays, roans may lighten with age as more white hairs appear over time.
Then there are the other color breeds: Paints, Pintos and Appaloosas. The skin color follows the hair color. If the hair is white, the skin will be pink. If it’s darker, the skin will be black. If it’s spotted, the skin will also be spotted. Paints and Pintos, although separate registries, basically look alike and come in two broad patterns: tobiano and overo. A horse with tobiano markings typically has normal face markings and patches of color spreading vertically down from the back and up from the legs. Horses with overo markings may have irregular facial markings and color patches which spread horizontally along the ribs, neck and body. Paints and Pintos can be a variety of colors: Palomino and white, black and white, brown and white, gray and white, or even black, brown and white. Their tales and manes may also be multicolored. One thankfully rare color is called lethal white.

This is an overo born all white or with just a few spots and blue eyes. Due to complications from defective bowels, these foals die a few hours after birth. You can’t miss an Appaloosa. These horses can have just a few spots on their necks, a “blanket” of spots covering their hindquarters, or be spotted from head to tail. Some Appaloosas even have spots on the whites of their eyes, on the skin under their tails, and striped hooves. So the next time you visit a horse show, you may think twice before commenting on that “white horse” in the ring!
By Ron Bukley Town-Crier Staff Report
The Royal Palm Beach High School boys varsity basketball team redeemed its two initial losses against Glades Central and Boca Raton high schools by defeating Seminole Ridge 60-51 at home Tuesday.
“Both teams we lost to were pretty good, but we’re implementing a new system, and there’s always going to be growing pains associated with that,” said Head Coach Drew Quinn, who is in his first year with the Wildcats.
“Doing things differently is always a process,” Quinn said. “The players are adapting to me, and I’m adapting to the players.” Quinn, who teaches calculus and trigonometry at RPBHS, comes from Summit Christian School where he was assistant basketball coach. He said he is very impressed with the athleticism of his current team.
“I feel once things mesh, we’re going to be fun to watch,” Quinn said. “We have a strong season, and we have five or six guards who are very good high school players.”
Three of the players are returning seniors. “Justin Lord is
an extremely athletic kid,” Quinn said. “Albert Pallante is a great shooter. He’s as much of a shooter as you can get. He was a finalist in the three-point shootout last year at the state tournament. Our big key, I think, is we have a very skilled big man, Brad Zambito. He makes great passes. He makes great decisions. He’s a good one-onone player, but he’ll also pass the ball up. Once we start using him, we should really be able to open up the driving lanes for our guards. We basically put four guards around him.”
Starting juniors John Octeus, Troy Stafford and Derrick Wood are in their first year with the varsity team and are all skilled shooters, Quinn said. “We had seven people make three-pointers in the first game, so we shoot the ball pretty well,” he said.
Quinn said RPBHS basketball games offer an affordable, entertaining evening for the entire community.
“We’re trying to make it a fun evening for everyone,” he said. “Tickets are $3, $2 for middle schoolers and $1 pre-sale for high school students. We’re really trying to make it an affordable evening for everyone and
get people excited about basketball at Royal Palm Beach.”
On Nov. 24, the Wildcats dropped a home game 76-62 against fifth-ranked Glades Central High School, although they led the entire first half, scoring 36 points.
“The offense slowed down in the second half and the Raiders were able to use their height advantage to grab countless offensive rebounds and putbacks,” Quinn said. “Wood had a very solid defensive effort against the Raiders, with four steals that he turned into eight easy points.”
Against Boca Raton Nov. 25, the Bobcats grabbed an early 142 lead to start the game.
“We battled back to get it to a 16-14 deficit, but never got close again,” Quinn said. “One bright spot was the intensity, toughness and competitiveness of Rob Marcello. Rob is an extremely talented baseball player who came out for basketball as a senior. Whether diving for loose balls, taking charges or playing tough defense, he has proven to be a real asset to the program.”
In Tuesday’s victory over Seminole Ridge, the Wildcats were trailing by 13 points at the end of the third quarter when

hit a three pointer with three seconds left to cut the deficit to 43-33. The Wildcats were able to secure their first victory on the strength of a 27-7 advantage in the fourth quarter.
“Our senior captains stepped
up and led us to a win against a very tough opponent,” Quinn said. “Hopefully this victory will provide a momentum boost as we enter the district portion of our schedule.”
Wildcats hosted Cardinal
By Paul Gaba Town-Crier Staff Report
Some 20 years ago, the gold standard for the hardwood “run ’n’ gun” were Loyola Marymount and the University of Nevada at Las Vegas. With players like Greg Anthony, Stacey Augmon, Hank Gathers and Bo Kimball, Jerry Tarkanian’s UNLV Runnin’ Rebels and Paul Westhead’s Lions excited fans by consistently pushing the ball quickly up the court and scoring in triple digits.
While Palm Beach Central High School first-year boys varsity basketball coach Peter Karas isn’t making claims of matching this success, he certainly wants his squad to give it a try.
“The system we like to play here is more conducive to athletes,” Karas said. “It will be an up-tempo style, from one end to
the other. We want to shoot the ball within three and a half to five seconds. We’re going to be more Loyola Marymount and less four-corner spread.”
Karas knows this approach will be a challenge.
“It takes a lot of guts to run this system, but I ran it at [Palm Beach Community College] because we didn’t have the personnel to run a half-court offense,” he said. “The amazing thing is, they all want to play this, but it’s more difficult to play than they think. We’ll need to be extremely disciplined on defense, because we will be giving [opponents] a lot of possessions. We have to limit the other team’s efficiency.”
Karas is also trying to build for the future. With five seniors on the roster, he needs to develop younger players to learn the system for an easier and im-
proved transition next year. “It would be nice to have guys step right in and know what they’re doing,” he said.
To help keep the tempo on the court, Karas realizes he will need a deep bench; interchangeable parts will be needed for oxygen breaks and to keep legs fresh. He’s carrying 15 players on the roster, with a definitive starting five: Kendall Johnson, Gabriel Wendel, Roody St. Germaine, Julian Owens and Max Marshall.
Johnson, a sophomore transfer from William T. Dwyer High School, “got a lot of good experience there,” Karas said, referring to the “monster program” that has been in place for years at Dwyer. “They know how to play and work there,” he said. Karas even made sure to put Dwyer on the schedule this season, “because I like to play the
best, and that’s our measuring stick.”
Johnson will take over the Broncos’ point guard position.
At shooting guard is Wendel. The junior “is without question our best perimeter threat,” Karas said. Wendel graced Palm Beach Central’s junior varsity squad in 2007-08.
Karas said the team’s best allaround athlete is St. Germaine, who is the lone returning starter from last season’s 8-12 program. The senior showed his athletic versatility by playing on the Broncos’ football team this year — his first venture into the sport.
Another football player who is part of the starting lineup is center Marshall. The 6’2”, 245lb. sophomore was most recently seen playing tight end on the field. Rounding out the starters is Owens, who also plays lacrosse
for the Broncos. “He’ll probably play lacrosse in college,” Karas said. “He’s a tough kid who does what you ask him to do. He works hard, does everything well, and is a leader by example.”
Seniors Josh Adler and Jeff Nacimento, as well as another former football player, D.J. Nelson, lead the bench. While Karas noted that the Broncos are in a tough district — with the likes of Palm Beach Gardens and Palm Beach Lakes high schools — he is not afraid to look at the end of the season already.
“Gardens is the frontrunner; they have four starters back. They’ll be a horse,” Karas said. “Lakes is Lakes. They always have athletes. They’re well coached and will come after you. Our goal is to finish in one of the top two places in the district tournament. What happens
between now and then is of no consequence.”
Along with his previous experience at PBCC, Karas has coached at Pope John Paul II, Inlet Grove, Boynton Beach and Pahokee high schools. While at Pahokee in 1995, he led the Blue Devils to a state final four appearance, and coached Pope John Paul to a state championship game four years later.
“I played baseball in high school, as well as basketball, but I was not good enough to play basketball in college,” Karas said. “I love basketball, but I was small at the time I went to college, so I went out for baseball instead. I went to Miami-Dade Community College. I came here from New Jersey with a dream of pitching for the Yankees.” Instead, he’s pitching his team a new offense.








Wellington Roller Hockey League’s Player of the Week is nine-year-old Tyler Lorenz, a member of the Prep Division Penguins.
In his position as the Penguins’ center and right wing, Lorenz shoots right. His jersey number is 4. Lorenz’s favorite professional hockey team is the Edmonton Oilers, and his favorite professional hockey player is Wayne Gretzky. Other favorites of Lorenz include his favorite video game, Dragon Ball Z, and his favorite food, pancakes. Tyler Lorenz

The 27th Annual Wellington Boys & Girls Club Golf Classic, presented by Builtx Land Development, was held recently at the Binks Forest Golf Club in Wellington. This event is the longest-running golf tournament for the Boys & Girls Clubs of Palm Beach County. Proceeds will go directly to help provide programming for more than 750 children served at the Boys & Girls Club of Wellington, as well as the 1,600 children served at the six Boys & Girls Clubs of the Glades area. This is the first year that the Glades area clubs are involved in the tournament.
Immediately following the tournament was an awards ceremony, silent auction and fantastic buffet luncheon. Hole-in-one prizes included a “Fat Boy” motorcycle courtesy Ameriprise Financial and Iron Eagle, a set of TaylorMade clubs courtesy of the Palm Beach Golf Center and a Lexus from Lexus of Palm Beach. During the tournament, food was provided on the course by Backstreets Bar & Grill, Dean Anthony’s Pizza Express and Duffy’s Sports Bar & Grill, along with numerous games and activities.
school holidays. The clubs’ activities promote health, educational, social, vocational, leadership and character development. Plans are currently underway for a new 21,000-square-
foot, state-of-the-art facility in Wellington to replace the existing building. For more information, call (561) 683-3287 or visit www. bgcpbc.org.
The Palm Beach County Premier 8-U travel baseball team is seeking skilled players who were born after April 30, 2000. Try-outs will be held Tuesday, Dec. 16 and Friday, Dec. 19 at 6 p.m. at Olympia Park in Wellington. Call (561) 379-3302 for more about the team.
The Royal Gemz All-Star cheerleading squads are holding evaluations throughout December for its upcoming competitive season beginning in January 2009. The season will run through mid April. The Gemz are currently seeking candidates for their Tiny, Youth, Junior and Senior teams. Evaluations are open to boys and girls ages four to 18. The Royal Gemz All-Star cheerleading squads will represent Palm Beach County at local, state and nationwide competitions. All competitions will be held in Florida this year. The Gemz have teams ranging from levels 1-5, and all candidates will be considered. For more information, visit the Royal Gemz web site at www.royalgemz. com or call Lori Sedore at (561) 315-5470.


Also celebrating 27 years are returning tournament co-chairs chair Ed Portman and Dennis Witkowski, who have been organizing the event since its inception. Joining Portman and Witkowski as co-chairs were Pat Evans, “J.R.” Reid, Gary Thomas and Steve Weeks. More than 112 golfers attended the event, which began at 7 a.m. with a putting contest and breakfast provided by Panera Bread.
Taking home first place were Fred Volpe, Danny St. Louis, Toby St. Louis and Rick Goss. In second place were Bobby Columbia, Jeff Salito and Brad Wilkerson, and coming in third were Gary Thomas, Laura Thomas, Steve LeBlanc and Donnie Pantell. The Longest Drive was shot by Bob Schweitzer.
The Boys & Girls Clubs are safe, supervised facilities for area children ages six to 18. The clubs are open after school, during the summer and on most










Saturday, Dec. 6
• The Rolex/USEF National Jumping Championship presented by Equine Motor Coach is the featured event of Holiday & Horses at the Palm Beach International Equestrian Center (14440 Pierson Road, Wellington), which continues through Dec. 7. For more info., call (561) 793-5867 or visit www.equestriansport.com.
• The Studio Theatre of Wellington (11320 Fortune Circle) will present An Implausible Claus by Nikki Harmon Dec. 6, 12 and 13. Tickets are $15 for evening performances, which include an outdoor music concert, tree lighting, activities and refreshments. The Dec. 13 matinee is $10 for adults and $5 for children and will include the performance and refreshments only. RSVP to (561) 204-4100.
• St. Rita Catholic Church (13645 Paddock Drive, Wellington) will hold Breakfast with Santa on Saturday, Dec. 6 from 9 a.m. to noon. Bagels, donuts, juice and coffee will be served. Photos with Santa will be available for $3. Bring an unwrapped toy for a needy child. For more info., call Caroline at (561) 798-2853 or Mary at (561) 753-8633.
• Florida Atlantic University’s Pine Jog Environmental Education Center (6301 Summit Blvd., West Palm Beach) will host “Go Green for the Holidays and Music in the Forest” on Saturdays, Dec. 6 and 13 from 10 a.m. to 4 p.m. Attendees will learn about exciting alternative gift options from Heifer International and the Nature Conservancy. For more info., call Tracey Ritchie at (561) 686-6600, ext. 419 or e-mail her at tritchi1@fau. edu.



















Monday, Dec. 8
• The Wellington library (1951 Royal Fern Drive) will host Baby Story Time on Mondays, Dec. 8, 15 and 22. Your baby will love the rhymes, finger plays, songs, books and toys. Times are 9:30 a.m. for babies under nine months and 11:15 a.m. for 10 to 18 months. Call (561) 790-6070 to pre-register.
• The Palms West Chamber of Commerce will host its Annual Holiday Luncheon at the Breakers West County Club on Monday, Dec. 8 starting at 11:45 a.m. For more info., call (561) 790-6200.
• The Wellington library (1951 Royal Fern Drive) will host English Exchange on Monday, Dec. 8 and 15 at 1 p.m. for adults. Practice English conversation skills with Paula Alexander. Basic English speaking skills are required. Call (561) 649-5495 to preregister.
• The Palm Beach School District Science & Engineering Fair will be held Dec. 8 and 9 at the South Florida Fairgrounds (9067 Southern Blvd.). Hours are 1 to 7 p.m. Monday and 10 a.m. to 6 p.m. Tuesday. Admission is free. Call (561) 793-0333 for more info.
• The Wellington library (1951 Royal Fern Drive) will hold Poetry Recital Practice on Mondays, Dec. 8, 15, 22 and 29 at 3:30 p.m. for children ages six to 12 who would like to perform in the library’s poetry recital. For more info., call (561) 790-6070 to pre-register.
Tuesday, Dec. 9
• The Wellington library (1951 Royal Fern Drive) will hold “Drop-In Story Times” on Saturday, Dec. 6, 13 and 20 for ages two and up. Times are 10:15 and 11:15 a.m. For info., call (561) 790-6070.
• The Cuillo Centre for the Arts (201 Clematis Street, West Palm Beach) and Actor’s Workshop & Repertory Company will present The Velveteen Rabbit on Saturdays, Dec. 6 and 13 at 11 a.m., Saturday, Dec. 20 at 11 a.m. and 2 p.m., and Monday, Dec. 22 at 11 a.m. and 2 p.m. For more info., call (561) 835-9226 or e-mail rduffy@cuillocentre.com.
• The Wellington Chamber of Commerce’s Business Showcase 2008 will be held on Saturday, Dec. 6 from noon to 5 p.m. at the Palm Beach International Equestrian Club on Pierson Road in Wellington. For more info., call (561) 7926525 or visit www.wellington chamber.com.
• Vietnam veteran Mike Carroll invites new veterans and their families on Saturday, Dec. 6 from 1 to 5 p.m. to his G&M Ranch (13522 North Road, Loxahatchee Groves) for an enjoyable afternoon of good clean fun. For more info., call (561) 586-3592.
• Enjoy an evening “Under the Tuscan Moon” at the Boys & Girls Club of Wellington’s 21st Annual Wellington Dinner, Dance & Auction on Saturday, Dec. 6 at the International Polo Club Palm Beach in Wellington. Tickets are $225 per person. For more info., call (561) 683-3287 or visit www. bgcpbc.org.
• The Palm Beach Community College Duncan Theatre (4200 Congress Avenue, Lake Worth) will present “Celtic Crossroads” on Saturday, Dec. 6 at 8 p.m. The concert incorporates seven world-class musicians fusing traditional Irish music, bluegrass, gypsy and jazz. All seats are $25. For info., call (561) 868-3309.
Sunday, Dec. 7
• The Wellington High School Mighty Wolverine Sound marching band will present a memorial concert in honor of Pearl Harbor Day on Sunday, Dec. 7 from 2 to 4 p.m. at the original Wellington Mall at the corner of Forest Hill Blvd. and Wellington Trace. Call Band Director Mary Oser at (561) 753-9444 for more info.
• The world-famous Lipizzaner Stallions will be at the South Florida Fairgrounds (9067 Southern Blvd.) on Sunday, Dec. 7 at 2 and 6 p.m. Visit www.lipizzaner.com for details.
• St. David’s-in-the-Pines Episcopal Church (465 W. Forest Hill Blvd., Wellington) will hold its annual picnic on Sunday, Dec. 7 at 2 p.m. For info., call (561) 763-1976.
• St. Therese de Lisieux Catholic Church (11800 Lake Worth Road, Wellington) will present “Emmanuel: The Story of Christmas” by the performer Tajci on Sunday, Dec. 7 at 5 p.m. For information about the performance, visit www.ido believe.com. To contact the church, call (561) 784-0689.
• The Wellington Village Council will meet on Tuesday, Dec. 9 at 7 p.m. at the Wellington Community Center. For info., call (561) 791-4000. Wednesday, Dec. 10 • The Kravis Center for the Performing (701 Okeechobee Blvd., West Palm Beach) will present “Marc Salem: Mind Games and All Those Things” Wednesday through Sunday, Dec. 10-14 in the Rinker Playhouse. Call (561) 832-SHOW or visit www.kravis.org for info.
• The Wellington library (1951 Royal Fern Drive) will host “Meet the Author: Roberta Sandler” on Wednesday, Dec. 10 at 7 p.m. for adults. This award-winning travel writer will discuss her book A Brief Guide to Florida’s Monuments and Memorials. A book signing will follow. Call (561) 7906070 to pre-register. Thursday, Dec. 11
• The Wellington library (1951 Royal Fern Drive) will feature “Pizza & Pages: So Yesterday” on Thursday, Dec. 11 at 6:30 p.m. for ages 12 through 17. Up for discussion will be Scott Westerfeld’s book about Hunter, a professional trendsetter who discovers what’s hot and sells information to advertisers. Pizza will be provided. Call (561) 790-6070 to pre-register.
• Your Bosom Buddies II will hold its holiday meeting on Thursday, Dec. 11 at Wellington Regional Medical Center (10101 W. Forest Hill Blvd.). The guest speaker will be laugh therapist Sherry Miller. The meeting will be held in the conference center at 7 p.m. For more info., call Abbe Felton at (561) 793-9802.
Friday, Dec. 12
• The Palm Beach Central High School Bronco Players will present High School Musical Dec. 12, 13, 15 and 16 at 7 p.m. Tickets cost $10 for students and $15 for adults; a 2 p.m. matinee show will be presented Dec. 13 for $5. Tickets can be purchased online at www.seatyourself.biz/bronco. For more info., call Gail Marshall at (561) 304-1035. • The Palm Beach Opera will present Rigoletto at the Kravis Center for the Performing Arts (701 Okeechobee Blvd., West Palm Beach) Friday through Monday, Dec. 12-15 in the Dreyfoos concert hall. Call (561) 832-SHOW or visit www. kravis.org for more info. • The Buckler Christmas Craft Show takes place Friday through Sunday, Dec. 12-14 at the South Florida Fairgrounds (9067 Southern Blvd.). Hours are 5 to 9 p.m. Friday, 10 a.m. to 5 p.m. Saturday and 10 a.m. to 4 p.m. Sunday. Call (561) 793-0333 for more info.
• “Christmas in the Village” will be held Friday through Sunday, Dec. 12-14 at the South Florida Fairgrounds’ historic Yesteryear Village. The traditional festival of Christmas lights, music, food and entertainment will take place from 5 and 9 p.m. each evening. More than 20 historic buildings will be decorated with everything from lights and giant wreaths to gingerbread men and toy soldiers. For more info., call (561) 793-0333 or visit www.southfloridafair.com.

By Ron Bukley Town-Crier Staff Report
Palm Beach County residents who want friendly and honest air conditioning installation and service should check out Sea Breeze Air Systems, owners Nancy and Terry Cook said.
Sea Breeze President Terry Cook started working in the air conditioning field in 1967, got his contractor’s license in 1980 and went to work for subdivision developer Burg & DiVosta in 1983, eventually heading up the air conditioning division of DiVosta Homes before establishing Sea Breeze in 2004.
Terry said he and his company, which includes his wife Nancy and son-in-law Ethan Baker, offer a wide range of services for residential and smaller commercial customers including sales and installation of air conditioning and heating units, maintenance and repairs, duct work and efficiency rating. The company is also an authorized contractor for the Volcano Pool Heating System, which keeps swimming pools warm using heat generated by a home’s air conditioning system.
Terry noted that there are enormous benefits in replacing an outdated, inefficient air conditioning system. “Depending on your location, they say 10 to 12 years is the maximum life of an air conditioning system to upgrade to a higher-efficiency unit,” he said. But due to the present economic climate, the Cooks do not stress replacement and will work with customers who want to get by with what they have.
“It’s significantly better to upgrade, but as tight as things are now, people tend to hang on to what they have,” Terry said. “If they don’t need to change it, we won’t change it. We’re not a pressure company.”
Sea Breeze Air Systems offers a pay-as-you-go schedule of maintenance twice, three or four times a year rather than selling annual maintenance contracts in which a customer pays up front,
Terry said. “What we do is suggest we come out twice a year or three times a year,” he said. “We have some customers who have us come out four times a year. Part of my job is to keep track of when we need to be going out and taking care of it so that they’re not paying us any more than what they actually need to be paying us. They’re not giving us a contract and then spending more than what the actual cost of taking care of the unit would be.”
If a customer prefers, Sea Breeze representatives will teach the client how to change or clean the air filter once a month and clean out the drip pan regularly. “Those are the two main things: change the filter monthly and keep the condensate drain clean,” Terry said. “It gets clogged up and backed up, and then you’ve got a flood in the house. If you do those two things, more than likely you won’t have problems with your air conditioning.”
Nancy said the company tries to educate its clients so they can take care of their unit if they choose to do so.
“If you have a business and you want us to come out every three months and clean your drains and all that so that you don’t have to worry about it, we will do that, but you don’t have to sign a contract with us,” she said. “If you want us to call and say it’s time to have service or maintenance done, and for some reason a client can’t afford it that time and ask us to put it off for a month or two, that’s fine with us. If you have a contract, you pay up front. We understand in this economy how things are tight for all of us, so we try to treat our customers the way we want to be treated.”
Terry added that some companies have customers on a monthly contract and try to sell them additional items or services when they come out. “We don’t do that,” Nancy said. “We’ve had contracting companies come to us wanting us to
become part of their business, and as we looked into it, we felt that’s not what’s best for us.”
Nancy said Sea Breeze offers second opinions on air conditioning problems, explaining that she gets calls from people who have been told that they need a new system.
“We will go out and often it’s something minor and Terry can fix it,” she said.
“A lot of times we can clean the system up and they don’t have to replace it; their unit’s fine,” Terry added.
With the rising cost of electricity, the Cooks said it is more important than ever to have an efficient air conditioning system. Terry went to Cocoa for training by the Florida Energy Gauge Program and is state-certified to rate a building’s energy efficiency, and is ready to offer recommendations if the customer is interested.
“I’ve been through a lot of homes where they have changed out the equipment, but the duct work is so bad that even though they’ve got new equipment, they’re losing all of their efficiency from their new equipment,” Terry said.
“We’ve gone in and redone ductwork to bring it up to standards.”
Sea Breeze is a member of the Palm Beach Air Conditioning Contractors Association and the Western Communities Business Association. The company’s two major brands are Lennox and American Standard, although they work on all brands, Terry said.
Nancy said the company is ready to serve customers whenever an emergency occurs. “We are available seven days a week,” she said. “We don’t charge more for after hours or weekends than we do during normal hours. We understand that peoples’ air conditioners don’t know time.”
For more information on Sea Breeze Air Systems, call (561) 964-3817 or visit the company’s web site at www.seabreeze airsystems.com.
‘It’s significantly better to upgrade, but as tight as things are now, people tend to hang on to what they have. If they don’t need to change it, we won’t change it. We’re not a pressure company.’
— Terry Cook of Sea Breeze Air Systems






























On Wednesday, Nov. 19, administrators and department managers at Wellington Regional Medical Center prepared to distribute turkeys as a thank-you to its employees and volunteers. Some of the employees chose to donate their turkeys to the Salvation Army. Pictured left are (L-R) Chief Financial Officer Woody White, Case Management Director Karen Medoff, Orthopedic Unit Director Anja Hehmann, Health Information Management Director Philip Baker and recruiter Jennifer Wilson.
Since 1968, Edwin Watts Golf, one of the largest golf retail operations in the world, has grown to become the destination for golfers who love the game. Last month, the company brought this passion to Wellington with the opening of a new store at 10530 W. Forest Hill Blvd. in the Shoppes at Wellington Green. Edwin Watts Golf opened its first store in Florida 40 years ago. Known as “America’s golf club,” Edwin Watts Golf offers the finest pro-line golf equipment, apparel and accessories. Stores give customers the feel of shopping in their favorite pro shop with features like indoor hitting bays, putting greens, golf memorabilia and even a golfer’s lounge equipped with a flatscreen television.
Customers will also enjoy the unique services and cutting-
edge technology Edwin Watts Golf brings to the area, including:
• Virtual Golf Simulator — This premium IST system allows users to virtually track the flight of any shot with different clubs. It also measures the shot’s velocity, launch angles, club speed, true spin rates and other variables.
• Vector Launch Monitor System — Vector Launch gives users exact measurements of ball speed, spin and launch angle in order to custom fit them with the right clubs for their game.
• Full-Service Club Repair Facility — This in-store facility can assist customers with the installation of shafts and grips, as well as change club length, lie and loft. Putter fittings are also available.
“We are excited to bring Edwin Watts Golf close to the res-
idents of Wellington,” Store Manager Danny Germaine said.
“We look forward to providing our new neighbors with the best products, most knowledgeable staff and competitive prices.”
The new store, located a quarter mile west of State Road 7 on Forest Hill Blvd., offers customers weekday hours from 10 a.m. to 7 p.m. The store will also be open Saturdays from 10 a.m. to 6 p.m. and Sundays from noon to 5 p.m.
Headquartered in Fort Walton Beach, Edwin Watts Golf is one of the world’s leading golf retail organizations. Founded in 1968 by brothers Edwin and Ronnie Watts as a small pro shop at the municipal golf course in Fort Walton Beach, today there are 73 Edwin Watts Golf stores across the southeastern United States. For more information about Edwin Watts Golf, visit www.edwinwattsgolf.com.

You may have heard of tornadoes that hit Wellington this summer, and you may be aware that parts of the Palm Beach Equine Sports Complex were affected. What you may not know is how Palm Beach Equine turned those circumstances into an opportunity to improve and expand their facility. After assessing the damage, they decided to replace the lost barn apartments with new stalls, offering more exhibitors the opportunity to experience the well-appointed, 45-acre facility, just a mile east of the Palm
Gift cards are a popular item this holiday season, and Riverside Bank wants consumers to be educated before making a purchase.
“Because we care about the people in the home towns we serve, we are providing the following tips for consumers to make better choices when purchasing gift cards this holiday season,” Riverside Bank Palm Beach County President Jeff Atwater said. The American Bankers Asso-
ciation Education Foundation suggests the following tips for consumers thinking of purchasing gift cards:
• Buy gift cards only from reputable sources. Stay away from online auction sites which may have counterfeit or fraudulently obtained cards.
• Some gift cards don’t have fees, but others do. Check the packaging for information on fees or look for a toll-free number or web site with full information. Some fees may be paid


in cash, but others deduct fees from the card.
• Check for an expiration date. Some gift cards expire. If your card does, you may not be able to use it after the expiration date. Find out whether the card can be reissued with a new expiration date, and what the fee would be for issuing a new card.
• Don’t buy it if anything looks suspicious, like if protective stickers have been removed or the codes on the back of the

card have been scratched off to reveal a PIN number.
• Have the store cashier scan the gift card you’re buying in front of you. This reflects the balance that you paid for it and protects against crooks who substitute worthless cards for the cards you think you are buying.
• Keep your original receipt if you need to verify the value of the card. Having the toll-free number that appears on the back of the card can be handy if your gift card is lost or doesn’t work.
• Never give your Social Security number, date of birth or any other private information to anyone when you purchase a gift card. No reputable company will ever ask for this information.
• A store gift card can often be used only at the store where it was purchased (or related stores). Some are used for purchases in selected malls. Other gift cards, such as those with a connection to MasterCard or Visa, can typically be used wherever their credit cards are accepted. Some gift cards allow you to get cash at an ATM. Since 1982, Riverside Bank

The

































































































































